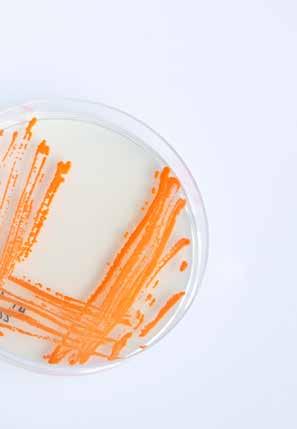

OPPDRETTSTEKNOLOGI
DET NORSKE LAKSEØYET:



I går – mandag 19. September 2022 - var en veldig spesiell og historisk dag for alle som var knyttet til Storbritannia, uansett hvor vi var eller hvor vi bor, da vi var vitne til, enten personlig eller på TV, Dronning Elisabeth IIs begravelse.
Jeg var i utlandet, i Italia på vei tilbake tilbake fra en forretningsreise. Men heldigvis fikk jeg se hele gudstjenesten og prosesjonen gjennom London på en gigantisk videoskjerm i Milanos Malpensa Airport mens Storbritannias Heathrow Airport ventet på å motta vår flight som var blitt forsinket på grunn av sikkerheten rundt begravelsen og overføring av kisten fra London til Windsor Castle, som skulle bli hennes siste hvilested. Det var svært rørende å se hvor høyaktet hun var utenfor Storbritannia. Stabiliteten og tilliten vår dronning har gitt oss gjennom sin tilsynelatende endeløse regjeringstid kan ikke undervurderes. Hun representerte det beste britiske, og det å være britisk handler ikke bare om landets tradisjoner, sport eller dets industrielle suksess i øynene til resten av verden, men også om mange andre ting, inkludert vår stryke innen landbruk. Og i nyere tid fra landbruk til akvakultur. Det er gjennom hennes internasjonalisme og spesielt hennes arbeid med Samveldet, som har gitt mange selskaper, som for eksempel vårt eget, tillit til å engasjere oss aktivt med andre land, spesielt utenfor Europa, i overføring av informasjon og teknologi – og britisk akvakultur har ikke vært noe unntak. Vi er veldig stolte over å være en britisk publikasjon som ser verden som et globalt samfunn, og vi er glade for å gi kunnskap som vil hjelpe alle land til å møte deres befolknings ernæringsbehov. Alle vi i International Aquafeed, både i Storbritannia og i utlandet, sender våre oppriktige kondolanser til Den Kongelige Familie på dette tidspunktet. Måtte Kong Charles III fortsetter Dronning Elizabeth IIs verdifulle internasjonale arbeid. Lenge leve kongen!
Roger Gilbert Utgiver – International Aquafeed and Fish Farming Technology
holdt i Utrecht, Holland fra 6.-8, 2022, med ikke mindre enn 118 foredragsholdere!
Denne konferansen var et dedikert møte på ledernivå for varmtvannsreke-industrien og ble fulgt av over 400 deltagere som representerte hele spekteret av grupper som er involvert i rekeproduksjon, fra oppdrettere, fôrselskaper, teknologi- og service-leverandører, til eksportører, importører, grossister, forhandlere og andre industri-interessenter.
På et mer beskjedent nivå har vi også sett publikasjoner som arrangerer en-dagers konferanser i forbindelse med messer - dette inkluderte vårt eget Aquatic Asia 2022-arrangement som ble holdt dagen før åpningen av den samlokaliserte Victam Asia 2022 og den første VIV. Animal Health and Nutrition 2022-arrangementet i Impact i Bangkok, Thailand.
I midten av september ble den franske landbruksmessen holdt i Rennes, og tiltrakk seg en av den største deltagelse noensinne. De arrangerte en én-dagers konferanse om akvakultur og presenterte de vel 100 utstillerne som hadde produkter og tjenester for den voksende oppdrettsnæringen.
Og denne månedens utvalg av oppdrettsarrangementer er ikke over når vi går i trykken - først og fremst European Aquaculture Society’s Aquaculture Europe 2022 som holdes i Rimini, Italia fra 27. til 30. september 2022. og hvor International Aquafeed skal ha en stand. Fokuset er på fisk og IAF er her for å gi deg det beste utvalget av nyheter som finner sted i vår bransje. Det er usannsynlig at vi vil se en nedgang i aktiviteter rundt formidling av høykvalitets, vitenskapsbasert informasjon.
Fra vårt perspektiv samler akvakultur økt oppmerksomhet fra arrangementene, konferansene og forretningsaktivitetene som har vært holdt siden Covid-relaterte reise- og møterestriksjoner er blitt trappet ned.
Det ser ut til at forskning og utvikling rundt produksjon av oppdrettsfisk, i form av ernæring og fôrproduksjon, ikke gikk i dvalemodus under de siste to-og-et-halvt årene, og vanskelighetene de ansatte møtte for å treffes og arbeide sammen. Et godt eksempel på et selskap som overvinner utfordringene som Covid-pandemien har ført til, er DSM. Oppkjøpet av Biomin, det østerrikske fôrtilskudds-firmaet som fokuserer sin oppmerksomhet på et bredt spekter av plantebaserte fôrtilsetningsstoffer og ingredienser, og som har et spesielt fokus på å adressere aflatoksin-forurensing av råvarene, har gått langt med hensyn til å integrere selskapet i sin virksomhet globalt, spesielt innen akvakultur.
I begynnelsen av denne måneden inviterte DSM kunder til å delta på sine 'Aquatic Days 2022' i Wien, et tre-dagers arrangement som tiltrakk seg vel 150 deltakere som lærte om det nyeste prosjektene selskapet har gjennomført og resultatene som er oppnådd. Rett i hælene på denne hendelsen ble det første Global Shrimp Forum
Vårt internasjonale tilbud denne måneden I denne utgaven fokuserer vår casestudie på levedyktigheten til erteprotein og tang som nye proteinkilder i produksjonen av økologisk seabream og regnbueørret, presentert av Alicia Estévez fra IRTA i Spania og Phelly Vasilaki i Irida sa i Hellas. Intervjuet med bransjelederen er med Pierre Pienaar, president i World Packaging Organization. Han er australsk statsborger og har et dobbelt professorat innen emballasjeteknikk.
Listen over akvafôr artikler inkluderer en vurdering av hvordan ett selskap validerer og omskaper korn til akvafôr av Laura Elphick og Cameron Davies fra EIT Food basert her i Storbritannia.
Under produksjonen av havremel lages biprodukter, også kjent som sidestrømmer. Denne artikkelen ser på hvordan EIT Food sitt Nordic Cereals-prosjektet utnytter sidestrømmene. Eksempler på disse biproduktene inkluderer havrefiber og havregrøt som er både rike på karbohydrater, og kan valoriseres inn i akvakulturfôr.
Et annet bidrag av Frederic Baron og Delphine Weissman fra det USA-baserte ADM Animal Nutrition, gir en detaljert beskrivelse av vitenskapen bak tidlig-stadiumsernæring for ferskvannsfisk, nemlig fôr for tilapiayngel.
Forfatterne beskriver hvordan det å opprettholde en konkurransedyktig akvakulturproduksjon krever komplette fôr tilpasset hver art på hvert livstrinn. De legger også til at yngelfôr må tilpasses riktige ernæringsmessige krav, inkludert fysisk pelletskvalitet, fôrinntak og ernæringsmessig effektivitet.
www.aquafeed.co.uk
Velkommen til min september-leder for International Aquafeed, som denne måneden har fokus på helse og ernæring –fortsett å lese for å finne ut hvorfor!

Takket være moderne teknologi skriver jeg denne lederen i 38,000 fots høyde over Sentral-Europa i en Airbus A380, på vei til VIV VICTAM-sponset møte i Bangkok sammen med mine kolleger i Perendale, Tuti Tan og Roger Gilbert.
Jeg skal være en av hovedinnlederne, og har dessuten bistått i organiseringen av vår Aquatic Asia énsdag konferanse. Mitt tema handler om sirkulær bioøkonomi og det konkrete fokuset på bruk av co-produkter som nye generasjons destillerte kornprodukter for oppdrettsfôr. Dette er neste generasjons høyproteinmaterialer og varsler stor endring og utvikling i bioetanolsektoren.
Det var en gang en viss kritikk av bruk av slike produkter basert på gjæring for etanol-produksjon fordi de trakk mais og hvete bort fra direkte konsum, men moderne teknologi har forbedret kvaliteten på anvendt korn med ny utvinning og fjerning av fiber fra co-produkter for å gi proteinrike ingredisenser med høyere verdi som kan fôres til monogastriske dyr som svin, fjærfe og fisk.
Selv om DDG har blitt brukt i slike sammensatte dietter i mange år, tilbyr disse nye typene bedre fordøyelighet og palatabilitet, og er en bedre kilde til tilgjengelig protein og essensielle aminosyrer. Jeg har nylig vært involvert i studier med mange fiskearter, og vi kan nå med sikkerhet bekrefte deres egnethet for å redusere bruken av mer tradisjonelle og mindre bærekraftige råvarer, som for eksempel fra det marine miljøet og til og med terrestriske kilder som soyabønnemel som er under press.
Verden gjennomgår en stor omveltning i øyeblikket og med de geopolitiske hendelsene i Ukraina som forårsaker mye forstyrrelser i fôrforsyningskjeden og eskalerende kostnader, er vi godt klar over at dette vil være en årsak til bekymring innen akvakultur. Dette gjelder spesielt i nasjoner som importerer fôringrediensene for oppdrett av fisk og reker.
En annen faktor har vært den store tørkeperioden i mange deler av verden. Spesielt i Europa har vi sett svært tørre forhold som fører til nedgang i vannreservoarene og i grunnvannet. Elver har lavere vannstand og der hvor vi har ørretoppdrett og andre arter som er avhengige av god vannforsyning, ser vi begrensninger i produksjonen.
De svært varme temperaturene over 30℃ har forverret situasjonen. Dette er fordi vannet inneholder langt mindre oksygen ved høye temperaturer, noe som deaktiverer effektiviteten av stoffskiftet og effektiviteten av næringsstoffassimilering. Som en følge av dette vil fôrkonverteringsforholdet bli påvirket negativt, og vekstratene blir alvorlig redusert, noe som fører til mye dårligere produksjon.
På den annen side har vi godt over gjennomsnittlig monsunaktivitet i Pakistan med kraftig nedbør, hvilket er en annen ekstremvær-hendelse. Oversvømmelser hvor over en tredjedel av nasjonen er dekket av vann, har vært katastrofale.
Dødsfall av mennesker og dyr, tap av eiendom, avlingsskader og uten tvil tap av oppdrettsanlegg også har blitt resultatet av dette.
Det ekstreme været er faktisk en realitet for de fleste forskere og de som opplever de direkte konsekvensene. Akvakultur og den tilhørende fôrsektoren kommer til å føle dette i økende grad i årene som kommer. Etter virkningene av Covid må vi være mer oppmerksomme på farer og katastrofer. Som fiskeernæringsforsker og fôrteknologiekspert med fokus på akvakultur ser jeg behovet for mye motstandsdyktighet i fremtiden og i synergi med miljøet.
Vi må vente det uventede, og derfor sikre oppdrettsnæringens fremtid og utvikle uavhengighet når det gjelder fôrforsyning. En måte vil være å raskt utvikle RAS-anlegg for å unngå eksterne trykk og for å maksimere bruken av dyrebare vannreserver.
Jeg har også vært talsmann for RAS-systemer i mange år gjennom min egen forskning og undervisning ved flere universiteter. Jeg støtter også utviklingen av nye fôrteknologier og potensialet til mer bærekraftige ingredienser fra lokale kilder i nærheten av produksjonsanlegg som er billigere og av høy kvalitet.
Det er varer som lupiner, bønner og pulser som kan være nøkkelen til dette, samt insektbasert fôrproduksjon og SCP. Selvfølgelig har vi rapportert her ved mange anledninger om bruken av alger, bakterielle og sopp-proteiner som gjær, samt det svært betimelig arbeid som utføres på da ulike former for insektmel.
DDG-historien er også svært anvendelig, gitt de eskalerende kostnadene på korn globalt. Det er med en viss lettelse at en avtale er nådd, takket være Tyrkia, til å tillate transport av hvete fra ukrainske havner i Svartehavet til de store eksportmarkedene i Midtøsten, Europa, Afrika, Asia og Kina.
For å komme tilbake til VIVs/VICTAM-møtet i Thailand, som vil bringe sammen en rekke interessenter fra hele akvafôrernærings- og helsedomenet. Mange vil samles i den første ansikt-til-ansikt konferansen i den kommersielle sektoren og med akademia på en så stor skala.

Jeg ser definitivt frem til å treffe gamle og nye venner underveis. Jeg har holdt av plass i kofferten min til alle de brosjyrer og produktspesifikasjonser som jeg kan ta med meg hjem. Jeg synes disse er svært nyttige for å lære om de nye teknologiene.
Messen vil være et uvurderlig utstillingsvindu for industrien, og Bangkok er et sentralt sted for akvakultur, gitt den veksten vi ser i Sydøst-Asia. Det vil bli et ukelangt besøk og mye å se i dette svært vennlige landet.
Uten tvil vil fisk og reker og andre sjømatdelikatesser stå på menyen i Bangkok, og jeg kommer sikkert til prøve den sjømaten som tilbys – og akvakultur vil uten tvil ha spilt en betydelig rolle for mange av artene.
Nyt vår sene sommerutgave og vær så snill å holde tritt med strømmen av nyheter, artikler og tekniske presentasjoner såvel som reklamen.
I slutten av august deltok jeg på Nor-Fishing-utstillingen i Trondheim. Utstillingen fokuserer på fiskeriteknologi, mens søsterutstillingen Aqua Nor fokuserer på akvakulturteknologi. Likevel var flere leverandører av havbruksteknologi til stede som utstillere. Og mange investorer, både i fiskeri og havbruk, var også på plass.
 Hempel Stiftelsen Nor-Fishing
Hempel Stiftelsen Nor-Fishing
Den enorme suksessen til norsk lakseoppdrett har naturligvis trukket mange investorer til disse arrangementene. Investering i akvakultur synes å være populært for øyeblikket. Landbaserte akvakulturprosjekter som Atlantic Sapphire i Florida, og andre virksomheter andre steder, får mye oppmerksomhet og fukter investorenes appetitt, enten de vet noe om akvakultur eller ikke. Gjennom årene har jeg sett mange investeringsprosjekter på dette feltet. Og jeg har sett mange feil. Den mest typiske feilen er underbudsjettering og at man undervurderer kostnadene for teknologien. Å investere i moderne storskala akvakultur krever store mengder penger. For den teknologien som trengs er ikke billig. Teknologi er heller ikke bare ‘maskinvare’ som flytende merder, nøter, pumper, fôringsautomater osv. Enda viktigere er den ‘programvaren’ som inngår i akvakulturteknologien. Det krever opplæring over tid, og det kan innebære å kjøpe ekstern kompetanse i den første tiden. Mange investorer nærmer seg akvakultur med begrenset kunnskap. Jeg husker hva en oppdrettsekspert fortalte meg da vi evaluerte et rekeoppdrettsprosjekt i Øst-Afrika for mer enn 30 år siden: – Denne investoren vet akkurat nok om akvakultur til å være farlig. Han kommer til å miste skjorten sin!»

Kunnskap er den viktigste delen av et vellykket investeringsprosjekt. Men dessverre vet de fleste investorer svært lite om detaljene innen akvakultur. De vet bare at noen mennesker – for eksempel i Norge – har blitt milliardærer som investorer i fiskeoppdrett. Og selvfølgelig er det forlokkende. Hvorfor ikke sette noen penger i akvakultur?
Kunnskap om markedet, biologi og teknologi er avgjørende. Markedet er kanskje det viktigste. Mange biologer blir begeistret

for muligheten til å dyrke en bestemt art når de har avdekket hemmelighetene til biologien og kontrollerer hele livssyklusen, og de glemmer å estimere markedet før de starter. Men hvis det ikke er noe marked for en bestemt art, hvorfor skal man da produsere den?
Cobia er en slik art. Den vokser utrolig fort, har et fint, hvitt kjøtt og en mild smak. Den så ut som en utmerket kandidat for storstilt, moderne akvakultur. Det ble imidlertid raskt tydelig at fisken ikke var veldig godt kjent i markedet.
Sportsfiskere kjente denne fisken og likte den fordi den ga dem en god kamp. Men hvem kjøpte cobia? Svært få. En produsent i Sydøst-Asia brukte mye penger på å gjøre fisken kjent i markedet. Men han hadde bare begrenset suksess. Å introdusere en ny art til markedet tar tid og mye penger. Å velge riktig teknologi er en annen snublestein. Investorer som ser på norsk lakseindustri tror ofte at den vanligste lakseoppdrettsteknologien er den rette også for andre arter. Så de kopierer det. Med begrenset suksess. Det som er riktig for laks er ikke nødvendigvis riktig for tilapia, for eksempel. Det viktigste er å tilpasse teknologien til de artene du produserer. Til slutt er tålmodighet også et viktig aspekt ved havbruksinvesteringer. Det tar flere år å få investeringen til å betale seg. Det finnes ingen "quick fix". Ingen rask profitt. Jeg vet ikke om en eneste fiskeoppdretts-milliardær som har blitt rik raskt. Det har tatt mange år med flittig, hardt arbeid og oppmerksomhet på detaljer. Akvakulturteknologien har utviklet seg enormt de siste tiårene, og innovasjoner og tekniske finesser blir fortsatt introdusert i et økende tempo. Det kan være vanskelig å holde styr på denne utviklingen. Det er det vi har utstillinger og konferanser for. Neste år kommer jeg til Aqua Nor-utstillingen i Trondheim igjen. Jeg er sikker på at det vil være mange potensielle investorer der også. Jeg håper bare at noen av dem vil ha lest hva jeg har skrevet her før de setter pengene sine i et oppdrettsutviklingsprosjekt.
Perendale Publishers Ltd
7 St George’s Terrace
St James’ Square, Cheltenham, Glos, GL50 3PT, Storbritannia
Tel: +44 1242 267700
Utgiver: Roger Gilbert rogerg@perendale.co.uk Ansvarlig redaktør

joyn@perendale.co.uk. Januar 1945
Internasjonale redaktører Dr. Kangsen Mai (kinesisk utgave) mai@perendale.com
Prof. Antonio Garza (spansk utgave) antoniog@perendale.com
Erik Hempel (norsk utgave) erikh@perendale.com
• Prof. Dr. Abdel-Fatlah M. El-Sayed
• Dr. Allen Wu
• Prof. António Gouveia
• Prof. Charles Bai
• Dr. Daniel Merrifield
• Dr. Dominique Bureau
• Dr. Elizabeth Sweetman
• Dr. Kim Jauncey
• Dr. Eric de Muylder
• Dr. Pedro Encarnação
• Dr Mohammad R Hasan
Redaksjonskomité:
Prof. Simon Davies sjdaquafeed@gmail.com
Andrew Wilkinson andreww@perendale.co.uk
Shannon Parsons shannonp@perendale.co.uk Niamh Cassidy niamhc@perendale.co.uk
Internasjonalt markedsføringsteam
Darren Parris Tel: +44 7854 436407 darrenp@perendale.co.uk
Latin-Amerikansk markedsføringteam
Clarissa Garza de Yta
Tel: +52 669 120 0140 clarissag@perendale.com
Cristina María Roldán Otero Tel: +44 1242 267700 cristinaperendale@gmail.com
Egyptisk markedsføringsteam
Mohamed Baromh Tel: +20 100 358 3839 mohamedb@perendale.com
Indisk markedsføringsteam Dr. T.D. Babu +91 9884114721 tdbabu@aquafeed.org

Asia markedsføringsteam
Dante Feng Tel: +886 0227930286 dantef@perendale.com
Nigeriansk markedsføringsteam
Nathan Nwosu Tel: +234 8132 478092 nathann@perendale.com
Design Manager
James Taylor på Commons jamest@perendale.co.uk
Circulation & Events Manager
Tuti Tan Tel: +44 1242 267706 tutit@perendale.co.uk
Utviklingssjef
Antoine Tanguy antoinet@perendale.co.uk

16 Bærekraftige fôringredienser: Hvordan korn blir valorisert og brukt til akvafôr 22 Fôrtil tilapiayngel 26 Algekarotenoider som pigment for salmonider: Utvikling av et realistisk og mer bærekraftig alternativ for akvakultur 30 Ekstrudert akvafôr: En ny teknologi for forbedret kvalitetskontroll
36 Det norske lakseøyet: En flytende utstilling viet akvakultur 40 Rekeroppdrett: Utvikling av en teknologipakke som er forutsigbar og enkel å administrere 44 Presisjonsfiskeoppdrett: Sykdomsforebygging med neste generasjons mikrobiomanalyse
Alge-karotenoider som pigment for salmoniderUtvikling av et realistisk og mer bærekraftig alternativ for akvakultur
Se mer på side 26
For ti år siden ble det første fiskeoppdrettsanlegget i verden som fikk sertifisering fra Aquaculture Stewardship Council (ASC) – Regal Springs' Lake Toba tilapia-anlegg på Sumatra i Indonesia presentert.

I tiåret siden har mer enn 1700 oppdrettsanlegg over hele verden tilfredsstillet ASC-standarden for å bli ASC-sertifisert. Det representerer for tiden nesten 2.5 millioner tonn sjømat og tang høstet per år – og en viktig, kontinuerlig transformasjon til miljø- og samfunnsansvar for akvakulturnæringen.
I dag er Regal Springs' Lake Toba tilapia-anlegg fortsatt ASC sertifisert, sammen med flere av deres tilapiafarmer på lokaliteter i Honduras og Mexico.
«På Regal Springs er vi veldig stolte over å ha vært en pioner her. Vi tok naturligvis med oss sertifiseringen som vi startet i Indonesia til Honduras og Mexico, sier Petra Weigl, administrerende direktør for Regal Springs i Europa.
«ASC-sertifisering gir oss en rekke fordeler, inkludert velorganiserte data,
som vi deler åpent gjennom ASCrevisjoner og rapportering; forbedret sporbarhet fra fôr til innhøsting, med den nye ASC Feed Standard som vil føre til enda flere forbedringer i fôrforsyning på våre anlegg, samt fortsatt forbedringer i samfunnsansvar internt og med eksterne samarbeidspartnere, legger Rudolf Hoeffelman, administrerende direktør i Regal Springs Indonesia.
«Samlet hjelper ASC-sertifisering oss med å kommunisere vår bærekraft og beste praksis til våre interessenter og kunder på en organisert og klar måte.»
ASC-standarder for 11 artsgrupper Tilapia-farmens sertifisering kom to år etter at ASC ble grunnlagt. På den tiden kunne bare to typer anlegg bli ASC-sertifisert – tilapia og pangasius. I 2022 finnes det nå ASC-standarder for 11 artsgrupper, noe som betyr at anlegg som oppdretter disse artene kan ta sikte på ASC-sertifisering.
Disse artsgruppene inkluderer abalone; skjell (muslinger, blåskjell, østers, kamskjell); flatfisk; ferskvannsørret; pangasius; laks; seabass, seabream og
meager; seriola og cobia; reker; tilapia; og tropisk marin fisk. Det finnes også en felles ASC-MSC-standard for alle typer tang.
– Hver reise begynner med ett enkelt skritt. I dag, den 15. august, var en viktig milepæl i vår reise med å transformere oppdrettsnæringen, sier Chris Ninnes, CEO ASC.
«Da det første anlegget i Indonesia ble sertifisert i 2012, skapte det en ringvirkning hos alle interessenter, fra oppdrettere til markeder over hele verden. Vi er glade for å se denne utviklingen i retning av ansvarlig akvakultur, og dette styrker vårt engasjement for å øke vår påvirkning massivt i løpet av de neste 10 årene, avslutter han.









Jeg kom til Roma for å delta på et møte i Committee on Fisheries (COFI) for femte gang med store forventninger om hva som kunne skje i denne trettifemte utgaven av COFI, selv om det var med en klump i halsen fordi jeg ikke ønsket å la min sønn fortsette å vokse i en uke, uten at jeg er der for å se det. Uansett hvordan man kommer til Roma, skuffer ikke byen, og den gjør at besøkende blir forelsket, eller forelsket på nytt, i den ved hvert besøk.
Imidlertid er historien om COFI anderledes.

På grunn av pandemien kommer du ikke til et levende og livlig FAO-hovedkvarter, men du blir mottatt i en bygning som fortsatt lever etter Covid-protokoller, hvilket føles sjelløs og trist.
På grunn av disse helserestriksjonene går svært få ansatte nå på jobb hver dag, og de som fortsatt er i stand til å arbeide hjemmefra gjør det. I denne situasjonen ser man det som en mulighet til å renovere store deler av bygningen.
Disse protokollene betyr også at ikke alle deltakerne er i samme rom. To delegater fra hvert land er invitert til plenumssalen, mens de delegatene som overskrider det tillatte antallet må sitte i den røde salen, mens observatørene (meg selv inkludert) alle måtte være i den grønne salen.
Uansett årsak føler man seg isolert og mulighetene til å samhandle med kolleger rundt om i verden er sterkt redusert. Tross alt, de få FAO-ansatte som har lov til å delta på arrangementet gjør det med entusiasme og dynamikk. Resten må se arrangementet på nettet fra sine hjem eller kontorer. Uansett hvor hardt jeg prøver, tror jeg vil aldri jeg vil bli vant til denne modaliteten som er her for å bli.
Hybridmøtet gjør det mulig å utvikle en agenda som domineres
av feiringen av det internasjonale året for småskala-fiskeri og havbruk, og hvor, som vanlig, ros øses ut over alle deltakere. Grunnleggende problemstillinger for sektoren ble deretter diskutert, som reduksjon av ulovlig, urapportert og uregulert fiske, tiltak som er nødvendige for å bekjempe klimaendringer, viktigheten av å opprettholde biologisk mangfold i fiske og akvakultur – i tillegg til anbefalingene fra akvakulturkomiteen. Alt dette er veldig viktig, men fra mitt personlige synspunkt, ikke som en representant for noen organisasjon, tror jeg ikke det er nok.

Etter hvert som årene går, mister man gradvis evnen til å undre seg, det er et trist faktum, men det er sant at det som har blitt levd før ikke oppleves på ny med samme følelser og intensitet. Kanskje var det det som skjedde med meg i forhold til COFI, eller ting har bare forandret seg litt, men under all glamour som disse komiteene representerer, eller pleide å representere, mangler en liten visjon og lidenskap.
Jeg tror det er veldig viktig, grunnleggende, at vi har et klart perspektiv på akvakultur som vi ser, alle sammen, i et perspektiv på 20 eller 30 år. Kanskje denne visjonen ikke vil være den samme i alle regioner eller land, men vi må også vite det. Etter å ha satt Shanghai-erklæringen på vent i den siste underkomiteen for akvakultur, uansett grunn, som ikke var teknisk, har man fratatt oss muligheten til å forestille oss en verden der akvakultur er en prioritet, hvor målet er å få familier ut av fattigdom gjennom velbetalende jobber, og ikke være det siste alternativet for mange.
Jeg tror at deaktiveringen av Shanghai-erklæringen forsinker den blå transformasjonen og konsolideringen av akvakultur over hele verden.
Jeg vet at jeg sannsynligvis er en ensom stemme i ørkenen, men i dag ønsker jeg å påkalle alle mine vitenskapelige venner, beslutningstakere og oppdrettere til å slå seg sammen og ta opp mange av punktene i Shanghai-erklæringen som må implementeres. Så snart som mulig.
Personlig tror jeg at FAO har gjort jobben sin, og av grunner utenfor deres kontroll kunne en årelang innsats ikke materialiseres.
Det er oss, og ingen andre, som skal ha styringen, uavhengig av nasjonalitet, trosbekjennelse eller ideologier. Vår forpliktelse til menneskeheten krever at vi fremmer akvakultur slik at det kommer på agendaen og fremfor alt inn i budsjettene i alle land. La oss alle fortsette på vår vei mot den blå transformasjonen.
Antonio Garza de Yta, har en PhD i akvakultur fra Auburn University. Han er President for Akvakultur uten Grenser, president for WAS og skaper av sertifiseringsprogrammet for Aquaculture Professional Program (CAP). Han er også redaktør for den spanske utgaven av International Aquafeed tidsskriftet og grunnlegger av det internasjonale senteret for strategiske studier for akvakultur. Han er i dag minister for fiskeri og havbruk i delstaten Tamaulipas.Mens akvakultur fremstår som ett av de bedre bærekraftalternativene når det gjelder global animalsk produksjon, ser bærekraften i fôrene som brukes i sektoren ut til å fortsette å vekke oppmerksomhet i media.
Kanskje ikke overraskende, da flere studier tydelig har indikert at mer enn 90 prosent av fotavtrykket i akvakultur er knyttet til fôrbruk. Så det var interessant å komme over en nylig artikkel som rapporterte om noen av de store laksefôrselskapenes innsats for å redusere sine karbonfotavtrykk [https://aqfeed.info/e/1594].
Både BioMar og Skretting har nevnt at man må bruke innovative tilnærminger for å løse denne utfordringen. BioMar indikerte tydelig at ved å adressere et oppfattet problem med marin ressursbruk, ble fôret presset i en retning som økte karbonavtrykket.
Så det var interessant å lese at de så sin fremtidige retning preget av sirkularitet og av å unngå produkter som hadde direkte human-forbruk (DHC) potensial, med bruk av ting som nye single-celle proteinkilder. Skretting, på den annen side, var relativt taus om sin respons, og sa bare at «vi vet at våre hotspots er knyttet til plante-proteiner... og jobber med en plan for å bidra til å oppnå reduksjoner», men utdypet ikke dette mer.
Å lese de ulike svarene fikk meg til å tenke på hvordan en sammenlignende livssyklusvurderings- (LCA) tilnærming for å sammenligne ulike oppdrettsfôr faktisk kan sees i forhold til hverandre og i forhold til noe sånt som fjørfeeller grisefôr. I det minste når det gjelder råvarebruk. Det store med å bruke en slik LCA-tilnærming til å vurdere bærekraften til en ingrediens er at den gir en klar objektivitet til prosessen, noe som dessverre virker altfor fraværende i mye av bærekrafthistorien.
Med tilgang til ressurser som Global Feed Lifecycle Assessment Institute (GFLI) database, blir det i tillegg en relativt rett frem fôrformuleringsøvelse, med bare behov for inkludering av noen ekstra parametere.

Så med det i tankene oppdaterte jeg min formuleringsdatabase til å inkludere globalt oppvarmingspotensial (GWP), ellers kjent som karbonfotavtrykk, ved hjelp av GFLI data, og gikk igang med å formulere en rekke akvakultur-, fjærfe- og grise-fôr (figur 1).
Nå er det ulike advarsler forbundet med en slik øvelse, men det jeg observerte var at en standard oppvekstdiett for laks (formulert som et 34% fordøyelig protein og 20 MJ fordøyelig energi) har en GWP (karbonavtrykk) på rundt 2250 kg CO2-ekvivalenter per tonn fôr.
Så langt som utvalget av formuleringer jeg utforsket gjaldt, STD laksedietten * var ganske høy sammenlignet med standard reke-, gris-, eller kylling-formuleringer. Selv om vi må være oppmerksomme her på at grise- og kyllingfôrkonverteringer er tre ganger og dobbelt så mye som laks.
Faktisk var grise- og fjørfe-formuleringer svært lave i sine fotavtrykk, drevet hovedsakelig av det lave avtrykket av hvete i disse eksemplene. Men øvelsen viste også at vi kunne legge inn begrensninger for å tvinge karbonavtrykket til å bli lavere.
Faktisk var det ikke så vanskelig, heller ikke så kostbart, å redusere karbonavtrykket fra 2250 kg CO2-ekvivalenter per tonn ned til 1600 kg CO2-ekvivalenter per tonn fôr. Denne begrensningen økte bare formuleringskostnaden med USD 53 per tonn, eller 3.2 prosent av Salmon STD-kostnadene. Den andre bemerkelsesverdige observasjonen fra denne øvelsen var endringen i råstoffbruk da jeg gikk fra et høyt til lavt karbonfotavtrykk. Her kan det tydelig sees at det var et press for å redusere planteproteiner og øke marine ingredienser, med en bemerkelsesverdig pådriver for å inkludere fiskemel basert på biprodukter. Så dette reiser et klart spørsmålet, i hvert fall i mine tanker, om hva som egentlig utgjør en bærekraftig ingrediens? Tydelig karbonavtrykk er bare én slik dimensjon i denne sammenheng, men det er ganske fremtredende i det 21. århundret, og en som bare sannsynligvis vil øke i betydning.
Figur 1: Globalt oppvarmingspotensial for forskjellige dietter formulert med samme råvarer med formuleringskostnaden (USD) vist ovenfor og formuleringsprofilen for hver vist som de forskjellige fargene (*laks STD: En standard europeisk formulering for en 40Pro (34 DPro):30Lip (20 MJ DE) lakseoppdrettsdiett; GWP=2000: Samme lakseformulering, men med GWP begrenset til 2000 kg/tonn CO2-eq; GWP=1800: Samme lakseformulering, men med GWP begrenset til 1800 kg/tonn CO2-eq; GWP=1600: Samme lakseformulering, men med GWP begrenset til 1600 kg/tonn CO2-eq; reker STD en standard SEAsian reker formulering for en 40Pro: 8Lip diett;
GRIS: En standard gris oppvekstformulering; KYLLING: En standard kylling oppvekstformulering). Alle data fra dietter formulert basert på GFLI oppskrift økonomisk tildeling til produkter basert på RER (European Sourcing) eller GLO (Global Sourcing) verdier, unntatt mel av sildeavfall som bruker data fra Dr. Richard Newton, University of Stirling.
 Dr. Brett Glencross er teknisk direktør i IFFO - Marine Ingredients Organization. I løpet av de siste 25 årene har han jobbet i ulike akademiske, institusjonelle og industrielle roller i Australasia, Midtøsten og Europa.
Dr. Brett Glencross er teknisk direktør i IFFO - Marine Ingredients Organization. I løpet av de siste 25 årene har han jobbet i ulike akademiske, institusjonelle og industrielle roller i Australasia, Midtøsten og Europa.
Iet forsøk på å takle det man kaller «ett av de mest presserende miljøproblemene i vår tid», er Mørenot for tiden involvert i et prosjekt for å utvikle et 2,5 km langt rensesystem for å fjerne marin plast fra havet.
I samarbeid med den nederlandske ideelle organisasjonen The Ocean Cleanup utviklet de en prototype i 2021 som viste seg å være svært vellykket og har samlet store mengder plast i Stillehavet.
Ocean Cleanup utvikler og skalerer opp teknologier for å fjerne plast fra verdens hav. En ny, forbedret utgave er under utvikling i et prosjekt med tittelen System 03, der Mørenot var valgt leverandør.
Etter testing av System 002 i innsamling av plast har den satt fokus på viktige områder der System 03 kan forbedre seg relatert til "overtopping" – dvs når plast rir bølgene og ikke blir fanget opp – samt utfordrende forhold i havet, krever vurdering av timing og valg av hvor du skal bruke systemet. Ifølge administrerende direktør
i Mørenot, Arne Birkeland, kan selskapet låne bort sin kompetanse fra oppdrettsnæringen til prosjektet. – Med mer enn hundre års erfaring fra fiskeri- og havbruksnæringen er det flott at vi nå kan bruke vår teknologi og kunnskap til å hjelpe Ocean Cleanup med å utvikle System 03, som er tre ganger så stort som det forrige systemet, forklarer han. – Vi er veldig entusiastiske for prosjektet og vi er stolte over å være en del av det. System 03 er tre ganger så stor som System 002 og er spesialdesignet og skreddersydd for innsamling av plast. Den er fire meter dyp og er utformet som en trakt med åpning nederst for å sikre at fisk og annet marint liv ikke fanges når man tråler etter plast.
To offshorefartøy vil trekke nettet mellom seg Nettet vil rydde opp i et område på størrelse med en fotballbane hvert 15. sekund, med potensial til å renske opp et område tilsvarende 6 000 fotballbaner om dagen.
I tillegg til å være tre ganger så stort som System 002, er det også i stand til å fange opp mye større mengder plast til en lavere kostnad per kilo hele året. Kostnadene for Ocean Cleanup er knyttet til støttefartøy, så ved å utvide
størrelsen på systemet for å fjerne mer plast per fartøy og ved å bruke et roterende tredje fartøy er det mulig for selskapet å redusere forventede kostnader per kilo plast som blir fjernet. – Rundt én til to millioner tonn plast ender opp i havet hvert år, og utgjør en enorm trussel mot alt marint liv, sier Birkeland. – Som en del av en industri som er avhengig av havet, er dette prosjektet svært viktig for oss, og vi vil alltid fortsette å utfordre oss selv til å gjøre enda mer for å beskytte havet som en viktig matkilde for fremtidige generasjoner.
Selskapet har som mål at System 03 skal være i drift i Great Pacific Garbage Patch mot slutten av sommeren i år.

MarinTrust skal holde et komplett
Sporbarhet er evnen til å spore et produkt fra salgsstedet tilbake til opprinnelsesstedet, med informasjon tilgjengelig om alle transaksjoner og bevegelser i mellom. MarinTrust vil holde et sporbarhetsseminar den 24. oktober 2022 i Lima, Peru, før starten av den årlige IFFO - The Marine Ingredients Organization - konferanse. Workshopen vil fokusere på veien mot full sporbarhet, med presentasjoner fra fôrprodusenten Vitapro SA og MarinTrust Certificate Holder Pesquera Centinela SAC som nylig har gjennomført piloter med MarinTrust for å implementere GDST. Organisasjonen vil fremheve hvordan innovativ sporbarhet har fungert for dem og hvorfor det er viktig, med ytterligere diskusjoner om viktigheten av sporbarhet av Francisco Aldon, administrerende direktør i MarinTrust, og et globalt perspektiv fra Global Dialog for Seafood Traceability's (GDST) sekretariat Frank Terzoli. En spørsmål-og-svar sesjon med et panel bestående av foredragsholdere vil aktivere publikum. For å fullføre arrangementet og fremheve fordelene ved samarbeid, vil Eva van Heukelom, Partnership Manager i Global Seafood Sustainability Initiative (GSSI), introdusere programmet sitt.

Hvorfor er sporbarhet så viktig? Svaret er at sporbarhet er avgjørende for mattrygghet, for å bevise lovlighet og for å verifisere ansvarlig innkjøp. Med sjømat som den mest globalt omsatte matvaren, er alle tre aspekter avgjørende, men frem til dannelsen av Global Dialog for Seafood Traceability (GDST) i 2017 var det ingen internasjonale standarder knyttet til dokumentasjon eller føring av sporingsprotokoller.
Denne dialogen har som mål å produsere et tilpasset globalt rammeverk for sporbarhet av sjømat basert på fire søyler: - Internasjonalt avtalte nøkkelelementer (KDE) som rutinemessig er knyttet til sjømatprodukter

- Tekniske spesifikasjoner for interoperable sporbarhetssystemer, sammen med standard juridiske og forretningsmessige formater som gjør det enklere å utveksle forretningsinformasjon - Internasjonalt avtalte benchmarks for å verifisere datavalidering - Harmonisering av forretningsorienterte nasjonale forskrifter for å bidra til å redusere byrdene ved å etterleve dem
GDST Standards er senere blitt utviklet og er nå vedtatt av mer enn 80 ledende internasjonale sjømatselskaper som har gitt uttrykk for sin hensikt om å implementere disse standardene over tid og anbefale bred adopsjon og implementering i hele sjømatnæringen globalt.
De har også blitt godkjent av globale initiativer og standarder, senest MarinTrust; den nye standarden MarinTrust Chain of Custody (CoC) følger GDST-standarder og materialer som forbedrer sporbarheten av marine ingredienser i verdikjeden.

Full sporbarhet krever imidlertid samarbeid mellom forsyningskjedeaktører og en større forståelse av hvordan og hvorfor sporbarhet kan oppnås. Registrer deg før 17. oktober ved å sende en e-post til standards@ marin-trust.com
Arrangementet finner sted i Salon Cusco 1 på Westin Lima Hotel & Convention Center, Calle Las Begonias 450, San Isidro, Lima 27, Peru.
is a blend of unique oleochemicals and active matrix selected for aquaculture application to help the reduction of parasitic challenges.



is a blend of natural products dedicated to stress management based on natural defenses stimulation and control thanks to anti-inflammatory and antioxidant effects.
is a natural solution specially developped for Aqua challenges leading to better economical results thanks to a wide spectrum modes of actions essentially linked to the gut balance modulation.



is a blend of Bacillus spp. strains dedicated to biocontrol in all aquaculture farming systems.






To support our customers to combine sustainability and economical performance
Pfiskefôr, har et EIT Food-prosjekt som er finansiert av et samarbeidsprosjekt, erfart. EIT Food er verdens største matinnovasjonsfellesskap som støttes av European Institute of Innovation and Technology (EIT).
EIT Food Nordic Cereals-prosjektet anvender biproduktene som produseres under prosessering av korn til fôr for oppdrettsnæringen. Under produksjonen av havremel lages det biprodukter, også kjent som sidestrømmer. Eksempler på biprodukter inkluderer havrefiber og havredextrin som er både rike på karbohydrater og kan valoriseres inn i akvakulturfôr.

Bruk av korn i akvakulturfôr kan ha økonomiske og miljømessige fordeler, som å gi et rimelig og miljømessig bærekraftig alternativ til andre fôringredienser som soya. – Vårt prosjekt vil ha stor innvirkning på ressursbruken med en observerbar økonomisk og miljømessig effekt, sier Elísabet Eik Guðmundsdóttir i det islandske FoU-bioteknologiselskapet Matís.
Funnene i prosjektet skal også gi grunnlag for fremtidig utvikling innen oppdrett og fôrproduksjon som kan ha innflytelse på hele næringen.
Den overordnede utfordringen i matsystemet vårt er å brødfø en økende global befolkning uten å ødelegge planeten. Oppdrett kan ha en viktig rolle i å brødfø verden på en bærekraftig måte,
For å fôre akvatiske arter på oppdrettsanlegg har man imidlertid i dag basert seg på kommersielt fiskefôr. Dette inkluderer soyabønnemel og fiskemel, og etterspørselen etter begge disse fôringrediensene øker. Likevel har soyabønner og fiskemel blitt kritisert for å være ikke-bærekraftige ingredienser som brukes i fôrproduksjon.
Soyabønnemel
Soyabønnemel kan brukes til å fôre både landhusdyr og akvatiske arter. Det produseres ofte i tropiske regnskoger som er avgjørende for å regulere klimaet og det biologiske mangfoldet.
Den økende etterspørselen etter soya fører imidlertid til avskoging. I Brasil, verdens største produsent av soya, er 20 prosent av regnskogen i Amazonas allerede blitt avskoget, og Amazonas er i fare for å bli en kilde til karbonutslipp i stedet for karbonvask (Animal Equity, 2021).
Som sådan er ødeleggelse av tropisk regnskog for å produsere fôr en pådriver for klimaendringer. Det truer også matvaresikkerheten ved å undergrave jordbruksproduksjonen og ved å øke havforsuringen, noe som skader livet i havet.
Bruk av fiskemel til fôr innebærer å bruke villfisk fra havet. Fiskemel brukes noen ganger til å fôre husdyr, men over 69 prosent av fiskemel og 75 prosent av fiskeoljeproduksjonen brukes til å fôre oppdrettsfisk (Compassion in World Farming,
Av Laura Elphick, Communications and Engagement Manager, EIT Food, StorbritanniaFangst og prosessering av fisk til fôr er ressurskrevende og har ført til at enkelte arter fôrfisk, som ansjos og sild, blir overfisket, og noen forekomster har kollapset.
Etterspørselen etter fiskemel og fiskeolje kan også overgå tilbudet av (Natur, 2018), så tidlig som i 2037 (The Coversation, 2020). Derfor er kommersielle fôr ikke bærekraftige på en industriell skala på lang sikt.
Nordic Cereals-prosjektet vil tilby et alternativ til soyabønner og fiskemel som fôringredienser. Fôringrediensen som utvikles er avledet fra havrefiber og havredextrin som er karbohydratrike sidestrømmer fra kornproduksjon.


Foreløpig tester prosjektet hvordan man kan konvertere disse sidestrømmene til materialer som kan utvikles til fôr. De komplekse karbohydratene (stivelse og beta-glukan) fra sidestrømmene er ikke direkte brukbare som fôr, så de


Enzymer spiller en grunnleggende rolle i denne transformasjonen. De komplekse karbohydratene blir omgjort til tilgjengelige mono-sakkarider og di-sakkarider (glukose og maltose, for eksempel) ved enzymatisk hydrolyse. De små sukrene brukes deretter av mikrober som gjær og melkesyrebakterier som tjener som enkeltcelleproteiner.
Ottevanger













Disse bioproduktene vil være kjerneelementene i det ferdige fôrproduktet.
Nedenfor kan du se noen eksempler på de første funnene fra EIT Food Nordic Cereals-prosjektet.
- Flere forskjellige enzymer kan brukes til å saccharify (omgjøring av stivelse til sukker) havrefiber fraksjon, økende fleksibilitet.
- Å eksperimentere med flere enzymer har vist at ved hjelp av en blanding av to-til-tre enzymer produseres en høyere avkastning enn ved hjelp av enkle enzymer.
- Ved hjelp av forskjellige kombinasjoner av enzymer bestemmes hvilke sukker som hovedsakelig produseres. Dette gjør at prosessen kan skreddersys til å produsere spesifikke enzymer i mer spesifikke mengder.
- Flere gjærstammer kan vokse på dette hydrolyserte materialet, inkludert stammer som har potensial som tilsetningsstoffer i akvakulturfôr. Sukkerkonsentrasjonen i supernatant form fra havrehydrolyse er minst tilsvarende et typisk gjærkulturmedium. Dette tyder på at sukkeret som produseres er tilstrekkelig til å brukes som potensielt fôr og ingen ekstra karbonkilde er nødvendig.
- Disse funnene viser potensialet i Nordic Cerealsprosjektet for å produsere akvakulturfôr fleksibelt og effektivt. Som sådan er det potensial for mer komplekse og spesifiserte fôr som kan utvikles i fremtiden.

I tillegg til å utvikle en bærekraftig fôringrediens for oppdrettsnæringen, tar Nordic Cereals-prosjektet for seg andre matsystemutfordringer.
Prosjektet fokuserer på produktivitet og trivsel for fisk i oppdrett. Oppdrettsfisk trenger spesifikke næringsstoffer som bidrar til å forbedre tarmhelsen og redusere dødeligheten. Nordic Cereals-prosjektet har som mål å levere de riktige fôroppskriftene som vil redusere dødeligheten og behovet for antibiotika, og dermed forbedre den totale produktiviteten i oppdrett.

Prosjektet fokuserer på å fremme en sirkulær tilnærming til matproduksjon. For eksempel innebærer «ta-lage-kast» produksjons-modellen å lage mange biprodukter som vanligvis går til avfall. Nordic Cereals-prosjektet øker sirkulariteten i oppdrettsnæringen ved å bruke færre ressurser og ved å gjenbruke avfall i prosessen.
Oppdrettsnæringen vil fortsette å vokse for å bidra til å øke mengden næringsrik mat som er tilgjengelig for menneskelig konsum og redusere presset på essensielle økosystemer som havet.
Alternative fôrkilder vil fortsette å utvikles på grunn av
begrenset tilførsel av soyabønnemel og fiskemel og den økologiske skaden de forårsaker i miljøet. Nordic Cerealsprosjektet viser at alternative proteinkilder som mikrober vil ha en nøkkelrolle i fremtidens mat, spesielt fordi mikrober har evnen til å omdanne avfallsmaterialer til verdifulle fôringredienser.
Ikke bare det viser Nordic Cereals-prosjektet at oppdrettsnæringen blir mer fleksibel. Funnene rundt rollene til ulike enzymer og hvordan de kan påvirke utbyttet, tyder for eksempel på at fôrformuleringen vil bli mer variert og kompleks i tråd med videre vitenskapelig oppdagelser.
Dette viser at det er potensial for ulike typer fôr som skal utvikles fra sidestrømmer, som kan ha applikasjoner ikke bare som akvakulturfôr.
EIT Food er forpliktet til å utvikle akvakultur til en bærekraftig form for matproduksjon. Utforsk noen av EIT Foods innovasjonsprosjekter for akvakultur nedenfor.
- Bærekraftig sjømatprosessering: Utvikling av nye
prosesseringsteknologier som forlenger holdbarheten til sjømat, men som ikke er avhengige av tilsetningsstoffer eller varmebehandling.
- Next Tuna: Reproduksjon av Atlantic Bluefin Tuna i et landbasert, miljøvennlig resirkuleringssystem.
- BREEZE: Et revolusjonerende og miljøvennlig konsept for fiskehelseledelse.
- Delta Futuro: Utvikling av et produksjonssystem for skalldyrjuveniler som reduserer variasjoner i yngelforsyningen for oppdretterne.
- AGAPE: En AI-basert samarbeidsplattform som støtter overgangen for akvakultur til en regenerativ og sirkulær form for matproduksjon.
- SustainFeed: Utvikling av nye bærekraftige fôr for marin fisk som bruker lavkarbon- og nullavfallsingredienser. For å lære mer: Www.eitfood.eu/discover/sustainableaquaculture
Nordic Cereals er et tverrfaglig prosjekt som involverer et bredt spekter av internasjonale interessenter innen næringsliv og akademia. Konsortiet inkluderer: Lund Universitet (Sverige), Matis (Island), University of Helsinki (Finland), Laxa Fishfeed (Island), Läntmannen (Sverige) og ImmuneBiotech, (Sverige).


EIT Food er verdens største matinnovasjonsfellesskap, og akselererer innovasjon for å bygge et fremtidsrettet matsystem som produserer sunn og bærekraftig mat for alle.
Med støtte fra European Institute of Innovation and Technology (eit), et organ i EU, investerer det i prosjekter, organisasjoner og enkeltpersoner som deler våre mål for et sunt og bærekraftig matsystem.





opprettholde en konkurransedyktig akvakulturproduksjon krever komplett fôr tilpasset hver art på hvert livstrinn. Yngelfôr må tilpasses med riktige ernæringsmessige krav, inkludert fysisk pelletskvalitet, fôrinntak og ernæringseffektivitet.
Å investere i riktig fôr i yngelfasen bidrar til å støtte fiskens ytelse, inkludert hvordan man bedre kan takle ytre stress og potensielle helseutfordringer gjennom hele livssyklusen.
Derfor har produsenter og forskere stor interesse for å fokusere ernæringsløsninger på de tidlige stadiene av fiskens liv for å maksimere vekst og ytelse – samt oppdretternes økonomiske suksess i vekststadiet.
Figur 1: Ung tilapia daglig vekst vs DP inntak
Det er viktig for de som utarbeider formuleringene å forstå karakterisering av råvarer og ernæringsmessige krav til ferskvannsfisk for å utvikle fôr med svært fordøyelige næringsstoffer.
I tillegg er næringsutnyttelse hos akvatiske dyr avhengig av fysiologi som endrer seg under fiskeveksten, noe som gjør det nødvendig å utvikle fôrformuleringer som er egnet for fisk av forskjellige størrelser.

Dette kan skape en utfordring for fôrformulatorer for yngel, da de tilpasser formler for å kombinere riktig mengde næringsstoffer i pellets av varierende størrelse for å sikre fullstendig ernæring for fiskearten. Tilpasning av fôrformler for vekst og ytelse bidrar til å sikre at fisken får de næringsstoffene den trenger mest, inkludert protein/energi, lipider, mineraler, vitaminer, funksjonelle tilsetningsstoffer og fordøyelsesenzymer.

Figur 2: Ung tilapia daglig vekst vs DP / DE ratio


hvor effektivt inntatte proteiner kan utnyttes av fiskeyngel. ADMs forsknings- og utviklingsanlegg i Vietnam gjennomførte studier og utarbeidet en metaanalyse som tydelig viser effekten av fordøyelig proteininntak på ung tilapia og veksten hos ferskvannsfisk (figur 1).

I tillegg optimaliserte det nøyaktige forholdet mellom fordøyelig protein og fordøyelig energi i diettformuleringene veksten og forhindret nitrogenholdige utslipp som forurenser akvatiske miljøer (figur 2).
Ferskvannsarter har ikke samme ernæringsavhengighet av svært umettede fettsyrer (HUFA; Omega 3) sammenlignet med andre marine arter. Dette gir dem muligheten til å desaturere og forlenge C18 essensielle fettsyrekjeden til en lengre HUFA. Likevel oppstår cellemultiplisering i yngelfasen, noe som skaper et behov for fosfolipider for å fullføre lipidprofilen til et yngelkosthold. Fosfolipider er viktige i yngelfasen og inneholder strukturelle bestanddeler av biomembraner som trengs for utvikling av fisken.
Mineraler, vitaminer og funksjonelle tilsetningsstoffer
Tilstrekkelig kosttilførsel av makro- og mikromineraler for oppdrettsfisk er fortsatt viktig for riktig somatisk og skjelettvekst, samt helse- og kjøttkvalitet. Ungfisk utsettes for en rekke stressfaktorer – blant annet håndtering, vaksinering, overføring mellom kultursystemer/anlegg, blanding av populasjoner, tetthet og vannkvalitet – som kan påvirke deres morfologiske strukturer og vekst i en tid da både immunsystemet og fordøyelsessystemet fortsatt er umodne.

Ved å inkludere en tilstrekkelig mengde spesifikke mineraler,
vitaminer og viktige funksjonelle tilsetningsstoffer i fôr av høy kvalitet, støttes ungfisken bedre for å bekjempe disse stressorene i et kritisk stadium av livet og senere.
Fôreffektiviteten for maksimal vekst hos dyr er avhengig av ernæringsprofilen og evnen til å konsumere, fordøye, absorbere og metabolisere næringsstoffer fra fôret. Næringsstoffutnyttelse i akvatiske dyr avhenger av fordøyelsesenzym-aktivitet, som endrer seg etter hvert som fisken vokser.
Fordi hver aldersgruppe har varierende fordøyelsesenzymaktivitet, har fisk også ulike ernæringsmessige krav i oppveksten, noe som gjør det til en nødvendighet å utvikle fôrformuleringer som er egnet for ulike størrelser av fisk.





Fiskeyngel vokser ekstremt raskt og må fôres flere ganger om dagen. Fôring av yngel med kvalitetsråvarer er avgjørende for å gi attraktanter og essensielle næringsstoffer til fisken tidlig.
Attraktanter og fôrinntak kan ytterligere økes ved hjelp av potente sentralstimulerende midler, som frie aminosyrer eller små peptider, under søken etter mat, deteksjon og anerkjennelse.
For å gi fullstendig ernæring til yngel og ungfisk, produseres fôrpellets med vår unike fôrteknologi. Høykvalitets pelletstrukturer må være stabile nok til å hindre partikler fra å disintegrere etter nedsenking i vann.

Pellets med god stabilitet opprettholder sin retensjon av vannløselige mikronæringsstoffer og begrenser den totale vannforurensningen. De bør også være tilgjengelige for ungfisk og ha en passende form og diameter – for å hindre overdreven næringslekkasje og oppnå god fordøyelighet og partikkelhomogenitet.
ADM bruker to teknologier for å produsere et utvalg av kvalitetsyngelfôr. Først bruker selskapet marumerisation teknologi for 0.2-, 0.3- og 0.5 mm pellet størrelser (figur 4).



Denne marumeriseringsteknologien inkluderer både kalde ekstruderingsprosesser og sfærisk prosess – som muliggjør kaldere temperaturer for å hindre at proteiner blir denaturert, mens forbedret fordøyelighet samt vekstytelse blir opprettholdt.
I tillegg skaper sfæronisering av fôret jevnt avrundet pellets og forbedret vannstabilitet av partiklene (figur 5).
For det andre gjelder ADM mikroekstrudering for 0.6-, 1.0-, 1.5- og 2.0 mm pelletstørrelser (figur 4), som produserer flytende fôr som er godt tilpasset ungfiskens atferd og oppfyller oppdretterens forventninger og krav til kvalitetsfôr (figur 6).
Støtter en kostnadseffektiv tilnærming
ADMs akvakultureksperter forstår ernæringsbehovene til fisk i alle livsstadier, og de utnytter en stor portefølje av ingredienser samt sofistikerte teknologier for å skape nøyaktig designede yngelfôr.

Spesielt tilbyr Ocialis-merket Nanolis P, et komplett fôr som bidrar til motstandsdyktig ferskvannsyngel og ungfisk, rettet mot høy ytelse under intensive forhold, og Nanolis Go, som støtter kostnadseffektivitets-tilnærming for semi-intensive yngelforhold.
Videre gir selskapets nye Nanolis Guard-fôr optimal pleie av fingerling-velvære og støtter ungfisken gjennom utfordrende faser av produksjonssyklusen for å sikre overlevelse, redusere stress og overvinne helseutfordringer. Oppdrettere som investerer i kvalitetsfôr i de tidlige livsstadiene bidrar til å sikre at fisken oppnår vekst og ytelsesmål i yngelfasen og senere.




Ikke alle produkter er tilgjengelige i alle regioner. ADM og dets varemerker gir ingen representasjon eller garanti, hverken uttrykt eller underforstått, om påliteligheten eller fullstendigheten av informasjonen.
Bruksområdene og påstandene skal tilpasses for å overholde gjeldende lokale/regionale regulatoriske miljø. Denne informasjonen innebærer ikke noen uttrykte anbefalinger for kur, reduksjon, behandling eller forebygging av sykdom.




Karotenoider gir den intense rødfargen på salmonidmuskler gjennom inkludering av det syntetiske pigmentastaxanthin (Axn). I akvakultur er syntetisk avledet Axn den dominerende kilden som inngår i akvafôr på grunn av lavere produksjonskostnader.
Alternative kilder til karotenoider fra bakterier, gjær eller alger har vært under utvikling i flere tiår, men har ikke blitt mye brukt, hovedsakelig på grunn av høye kostnader. Som naturlige antioksidanter nøytraliserer karotenoider frie radikaler og hos mennesker har det vist seg å forebygge eller bremse kroniske sykdommer, celleskader og aldring.
Spesielt er de kjent for å redusere risikoen for betennelse, hjertesykdom og kreft, type 2 diabetes, kroniske øye- og makulasykdommer, fedme og nevrodegenerative lidelser (Sathasivam et al 2018).
Skalerbar og kostnadseffektiv produksjon av algekarotenoider
Det er gjort betydelige fremskritt i produksjonen av
karotenoider fra alger, som omfatter flere algearter og karotenoidforbindelser (Ambati et al 2019). Den ferskvannsmikroalgen Hematoccocus pluvialis viser stort potensial som en kilde til naturlig ren Axn. Den kan dyrkes fra rene kolbekulturer til store områder av omkretsede fotobioreaktorer (figur 1) til bruk i nutrasøytisk, kosmetisk og næringsmiddelindustri.
Gjennom mange år med kulturinnovasjon har Yunnan Alphy kunnet produsere opptil 160 tonn algebiomasse årlig med et Axn-innhold på 3-5 prosent. Etter å ha optimert og ekspandert algebiomasse i den grønne vekstfasen, vil stressende forhold som sterkt sollys, vannkjemi og temperatur føre til at algene produserer Axn som en måte for cellen å beskytte seg mot det «tøffe» miljøet.

Dette fører til at algene endrer seg fra grønt til rødt. Axnakkumuleringsperioden er rundt 15 til 22 dager, avhengig av sesong med produksjon gjennom hele året. Produktet har mange produksjons- og matvaretrygghets-sertifiseringer som økologisk og EU ny mat. En slik skala for produksjon og Axn-innhold gjør nå algekarotenoider til et realistisk alternativ for akvakultur.
Sammenligning av pigmentkilder i ørret
I en nylig studie (Wang et al, upublisert) ble regnbueørret dyrket under kommersielle forhold, fra 0.6 kg til over 2 kg på dietter
som inneholdt 30 mg/kg Axn fra forskjellige kilder: Syntetisk Axn (Carophyll Pink); gjær Axn – Phaffia rhodozyma; algal Axn – H. pluvialis; Ingen Axn – intet ekstra tilskudd.
Resultatene viste at Axn-kilden ikke påvirket vektøkning, somatiske indekser eller pigmentering av kjøttet, noe som viste at ingen av karotenoidkildene hadde noen effekt på produksjonsytelse eller produktkvalitet.
Imidlertid hadde leveren hos fisk fôret med algekarotenoider betydelig økt total antioksidant-kapasitet, mens total lipidinnhold ble betydelig økt i muskelen.
Disse resultatene tyder på at alge-Axn kan gi ekstra nytte i perioder med økt miljøbelastning. Alle karotenoidkilder representerer levedyktige kommersielle alternativer for å produsere sunn fisk med høykvalitets filet-attributter.
Forbedret fordøyelighet av algekarotenoider i
Når Axn er inkludert med 50 - 60 ppm, kan det stå for opptil 25 prosent av fôrets kostnad.. Likevel var samlet oppbevaring







i muskelen ofte mindre enn 10 prosent. Fordøyelsen, absorpsjonen og avsetningen av Axn påvirkes av faktorer som Axn-kilde, inklusjonsnivå i fôret og sammensetningen av fôret.
Axn fra alger er esterifisert, en naturlig endring der en fettsyre er festet til en eller begge ender av karotenoidmolekylet, som også kan påvirke fordøyelsen. I en studie av atlantisk laks (Courtot et al 2022) ble det vist at alge-Axn var betydelig høyere enn syntetisk Axn.
Videre viste den tilsynelatende fordøyeligheten (AD) av Axn å bli forbedret ved kosttilskuddsinkludering av canolaolje i stedet for fjærkreolje eller talg (figur 3). Disse oljene varierer markant i fettsyresammensetningen, med canoolaolje beriket med monoumettede fettsyrer (MUFA), mens talg ble beriket med mettede fettsyrer (SFA).
Dette førte til at Axn-fordøyeligheten var sterkt positivt korrelert med innhold kostholds-MUFA, spesielt 18:1n-9cis som en av de viktigste fettsyrene i canolaolje. Dette resultatet gir bevis for at type og sammensetning av olje gir betydelig forbedring av alge-Axn fordøyelighet, som forventes å føre til forbedret utnyttelse og muskelretensjon.
Oppsummert kan vi si at inkludering av algebiomasse som kilde til naturlig Axn, kombinert med inkludering av MUFA-rike oljer som canola, føre til betydelige forbedringer i bruken av kostholds-Axn, og dermed gi en mer kostnadseffektiv produksjon av atlantisk laks av høy kvalitet.
Ambati, R. R. R., D. Gogisetty, R. G. Aswathanarayana, S. Ravi, P. N. Bikkina, B. Lei og Y. P. Su (2019). Industrial potential

of carotenoid pigments from microalgae: Current trends and future prospects. Critical Reviews in Food Science and Nutrition 59(12): 1880-1902.
(En) Courtot, E., D. Musson, C. Stratford, D. Blyth, (en) N. A. Bourne, A. N. Rombenso, C. J. Simon, X. G. Wu og N. M. Wade (2022). Dietary fatty acid composition affects the apparent digestibility of algal carotenoids in diets for Atlantic salmon, Salmo salar. Aquaculture Research 53(6): 2343-2353.
Sathasivam, R., & KI, J. S. (2018). A review of the biological activities of microalgal carotenoids and their potential use in healthcare and cosmetic industries. Marine drugs, 16(1), 26.
Wang L, Long X, Sun W, Li Y, Wang X, Zhang Y og Wu X (2022). Effects of three different sources of dietary Axn on the growth performance, coloration, and antioxidant capacity of rainbow trout Oncorhynchus mykiss. Under review.
Som vi alle vet, har noen prosesseringsparametere i ekstrudering, for eksempel vanntilsetning, temperatur, trykk og skruehastighet, en direkte og kritisk effekt på kvaliteten på ekstruderte produkter. Disse parametrene bestemmer stivelsens gelatinisasjonsnivå for fôrelting i ekstruderen, skjæringseffekten på den, ekspansjonsforholdet mellom flytende pellets, viskositeten og samhørighet av de synkende, og deres bulktetthet og vannholdbarhet.
Med bevisstheten om produktivitet, kostnader, dyrehelse og trivsel, og økende miljømessig bærekraft, vier oppdretterne i dag mye mer oppmerksomhet til slike fôrkvaliteter som bulktetthet, olje-/fettinnhold, vannbestandighet og utvasking av olje og andre næringsstoffer i vann. De ber om fôr med mer nøyaktig eller tilpasset næringsinnhold og fysisk kvalitet for å oppdrette fisken sin og tar sikte på mere økonomiske og bærekraftige fordeler.
Dette er en stor utfordring for akvafôrindustrien. For de fleste eksisterende fôrprodusenter er kvalitetskontroll av produktene og justering av prosesseringsparameterene alltid avhengig av dyktigheten, kunnskapen og erfaringrn til ekstruder-operatørene.
Før et nytt produkt lanseres på markedet, må dyktige ekstruderoperatører gjøre mye prøving og feiling for å utvikle de mest egnede produksjonsløsningene for den nye formelen, inkludert parameteren justeringspraksis for ekstrudere.
Det betyr mye mer investering i tid, arbeid og energi og mye materiale og spillvann i forsøkene.

stort "hvis"
De diversifiserte fôrkravene, sammen med presisjonsoppdrett, krever mer fremtidsrettede akvafôr-produksjonsteknologier. Hos Famsun har forskerne gjort en stor forutsetning: Hvis en gruppe pålitelige matematiske modeller er tilgjengelige for å forutsi produktkvaliteten til et ekstruderingssystem, vil den kostbare prøveproduksjonen ikke være nødvendig lenger, og produsenter
Tabell 1. Prediksjonsmodell - ekstrudert fôrkvalitet knyttet til ulike akvatiske arter Fôr Respons Ligning
Sea Bass Bulktetthet 378 - 19 x κ + 19.5 x γ - 29 x κ² + 23.5 x γ²

DG 68.6 + 2.35 x κ - 7.35 x γ + 9.05 x κ² - 2.25 x γ²
WAI 96.95 + 16 x γ + 30 x κ² + 26 x γ²
Catfish Bulktetthet 355 - 4.2 x γ - 5.8 x κ² +14,2 x γ²
DG 78.95 + 1.91 x κ + 4.82 x κ² - 5.91 x γ²
WAI 175.74 - 15.19 x κ² + 21.59 x γ²
Stør Bulktetthet 621 + 20.83 x γ - 22.5 x κ² +37.5 x γ²
DG 68.65 + 6.47 x κ - 6.01 x γ
WSI 11.72 - 0.41 x κ² - 0.795 x γ² - 0.3725 x κ x γ
Cray Bulktetthet 640 - 2.5 x κ + 10.8 x γ - 12.5 x κ² + 32.5 x γ²
DG 78.78 + 5.31 x κ² - 8.51 x γ²
WSI 12.43 + 0.675 x κ² - 0.54 x γ²
Tabell 2. Prediksjonsmodell - sammenligning av temperatur og fuktighet innhold Fôr Variabler Ligning
Sea Bass
Catfish
Stør
Temperatur 6 x κ + 122
Fuktighetsinnhold 0.8 x γ + 22.6
Temperatur 2 x κ + 124
Fuktighetsinnhold 0.4 x γ + 22.8
Temperatur 4 x κ + 78
Fuktighetsinnhold 0.8 x γ + 32.6
Cray Temperatur 4 x κ + 78
Fuktighetsinnhold 0.8 x γ + 29.6
Av Dr. Yang Chen, Senior Mechanical Engineer, Famsun, Kinavil kunne finne de beste behandlingsparametrene for å produsere sine nye produkter effektivt så snart de nye formlene er etablert. Det eneste du må gjøre er å definere kvalitetsparametrene for de nye produktene. Med kvalitetsprediksjonsmodeller vil produsentene være i stand til å akselerere tempoet i å få nye produkter på markedet, være mer fleksible med forskjellige (tilpassede) formler, og oppnå den beste samlede utstyrseffektiviteten (OEE) og Yield (YE) for sine fôrproduksjonsanlegg også.


I 2021 utviklet Famsun FoU-eksperter et sett matematiske regresjonsmodeller basert på solid statistisk teori og rik erfaring med bruk av big data-teknologi.



Ekspertene brukte ANOVA multi-parameter koblingsmetode for å utføre regresjon på behandlingsparametrene til FAMSUNs dobbelt-skrue ekstrudere. Kombinert med kvalitetsindikatorer som bulktetthet, gelatinisering og vannbestandighet, fikk forskere mange matematiske modeller for å forutsi kvaliteten på ekstruderte akvafôr produsert av ekstruderingssystemer med dobbeltskrue.
Prediksjonsmodellene er klassifisert og lagret i Famsuns kvalitetsprediksjonmodell-database i henhold til fôr-formel, skrue konfigurasjon, og diameteren på dysen. Etter hvert som mer data om de beste akvafôr-produksjonspraksiser brukes i etableringen av modellen, vokser databasen og gir større nytte til flere Famsun-ekstruderbrukere.

Regresjonsmodellene har vist seg å kunne forutsi ekstrudert produktkvalitet nøyaktig og pålitelig i FAMSUN-partneres fôrfabrikker. Kvalitetsparametrene til produktet som produseres av ekstruderen, er de samme som det som forutsies i henhold til de faktiske behandlingsparametrene.
På den annen side, ved å legge inn produktkvalitetskravene, vil
Figur 2: Bulktetthet for seabass i forhold til temperatur og fuktighetsinnhold
Figur 3: Gelatiniseringsnivå av seabass i forhold til temperatur og fuktighetsinnhold

backstage-databasen beregne de anbefalte prediksjonsmodellene automatisk og gi det beste forslaget til oppstartsparametere for nye produksjoner. Kvalitetsprediksjonsmodellene gjør det mulig for fôrprodusenter å tilfredsstille på kundenes krav raskt og dermed målrette fortreffelighet i drift.

Kvalitetskontrollpraksis
Famsun H-serien ble lansert i 2018 og er karakterisert ved utmerket produksjonsstabilitet, fremragende formelfleksibilitet og enkle operasjoner.[Se Figur 1] Så langt har det vært over 100 sett av H-serie-ekstrudere som skaper suksesshistorier i selskapets kunders fôrfabrikker i Vietnam, Thailand, SørAmerika og andre viktige oppdrettsmarkeder i verden.

Samarbeidet mellom Famsun og brukere av H-serie ekstrudere har nå oppnådd sine mål i Fase 1, og det er nå et samarbeid mellom brukere av Famsun og H-serien om forskning, tester, studier og bruk av akvafôrkvalitetsprediksjon og kontrollteknologi. Forskerne utarbeidet mange regresjonsmodeller ved hjelp av ANOVA multi-parameter koblingsmetode for å teste kvalitetsdata for ekstruderte produkter og tilsvarende behandlingsparametere, og ved å bruke en påvirkningsfaktor på p<0.05 og dens koeffisient.
Med MATLAB konturoverflategrafen, er forholdet mellom fôrvalitet og ekstruderingsprosesseringsparametere beskrevet visuelt. For kritiske kvalitetsindikatorer som bulktetthet, gelatinisasjonsnivå, vannbestandighet og vannabsorpsjonskapasitet utføres regresjonsprosessen separat, og regresjonsmodellen beskriver bare forholdet mellom en individuell kvalitetsindikator og prosessparametrene.







Alle prediksjonsmodeller er klassifisert og lagret i databasen i henhold til fôrformel og dyseåpning. For nye produksjoner vil backstage-databasen beregne de anbefalte prediksjonsmodellene og gi det beste produksjonskontrollforslaget om smeltetemperatur i ekstruder og damp- og vann-tilsetningsmengde under kondisjonering, når den målrettede produktkvaliteten er definert og Input, som sikrer akvafôrproduksjon i en høyeffektiv, lav-forbruks, og med mindre avfall.
Tabell 1 viser en gruppe kvalitetsprediksjonsmodeller av ekstruderen i Famsun H-serien som FAMSUN undersøkte, testet og verifiserte i samarbeid med en fôrfabrikk i Zhejiang i
Figur 4: Databasesøking og anbefalte oppstartsparametereKina. Fabrikken produserer fôr for fire typer akvatiske arter.

Den er tilgjengelig i tre eller fire kvalitetsprediksjonsmodeller for hvert eksemplar som dekker kvalitetsindikatorer for bulktetthet, gelatiniseringsnivå, vannabsorpsjonskapasitet og vannbestandighet, og har en påvirkningsfaktor på p<0.05 og garanterer R2>0.95.
X- og y-parametrene representerer smeltetemperaturen i ekstruderen og fuktighetsinnholdet i fôret under kondisjonering henholdsvis (-2: 0.05: 3), og den tilsvarende behandlingsparameteren for temperatur- og fuktighetsinnhold vises i tabell 2.
Med MATLAB 3D konturoverflate-grafen vises det visualiserte forholdet mellom seabass bulktetthet og prosesseringsparametrene for smeltetemperatur og fuktighetsinnhold i figur 2.



Smeltetemperatur og bulktetthet viser en positiv korrelasjon først, og deretter er den negativ, mens fuktighetsinnholdet av kondisjonert fôrmos viser en negativ korrelasjon med bulktetthet først og deretter en positiv korrelasjon.
For stivelsesgelatinisasjonsnivået er først negativt korrelert med smeltetemperaturen, og deretter positivt korrelert, og forholdet til fuktighetsinnholdet presenterer den motsatte situasjonen (se figur 3).
Det er åpenbart at forholdet mellom gelatiniseringsnivå og smeltetemperatur og fuktighetsinnhold er motsatt av bulktetthet med smeltetemperatur og fuktighetsinnhold, hvilket bekrefter ekstruderingsekspertisen at et høyt gelatiniseringsnivå alltid resulterer i et høyt ekspansjonsforhold og lav bulktetthet av det ekstruderte produktet.

Alle prediksjonsmodeller klassifiseres først i henhold til formelen, og deretter klassifiseres formler for de samme fiskearter videre i henhold til dyseåpningene. Med MATLAB-beregning vil databasen automatisk søke etter de anbefalte modellene i henhold til produktkvalitetsparametere.
Etter å ha definert den ønskede kvaliteten, for eksempel bulktetthet, gelatinisasjonsnivå, vannabsorpsjonskapasitet, vannholdbarhet osv., vil backstage-programmet beregne automatisk i henhold til de anbefalte prediksjonsmodellene og utgangsforslag på oppstartsparametere for ekstruderen (se figur 4)
Kvalitetsprediksjon og kontrolldatabase er nå tilgjengelig i Famsun Extruder Automatic Control System. Med denne funksjonen kan operatørene ha de riktige behandlingsparametrene for å produsere kvalifiserte produkter så raskt som mulig, unngå å miste produksjonstid i forsøk og slike krevende kvalitetstester som vannabsorpsjonskapasitet og vannbestandighet.
I tillegg bidrar den intelligente funksjonen til å redusere avhengigheten av erfarne operatører og fremmer vitenskapelig og økonomisk produksjon i fôrfabrikker.

Ved å kombinere intelligent kvalitetspåvisning og kontrollteknologi med automatisk kontroll på høyt nivå basert på toppmoderne ekstruderinger gir Famsuns ekstruderingsløsninger rask oppstart, helautomatisk dampvanntilsetning og kvalitetskontroll i ekstrudering av fôret.
Det bidrar til å forenkle driften og gi produsenten kraftig kapasitet, fleksibilitet og effektivitet for å møte oppdretternes krav i dag og i fremtiden.




Om å informere og inspirere verden Lakseøyet ble nylig avduket midt i Hardangerfjorden, og er Norges nye forum for innovasjoner innen bærekraftig sjømatproduksjon. «Det er nå det virkelige arbeidet begynner. Vi vil informere og inspirere verden til å utnytte ressursene i havet på en bedre måte, slik at verdens voksende befolkning har tilgang til god, sunn og bærekraftig mat som ikke ødelegger planeten, sier Sebastian Torjussen, administrerende direktør for Lakseøyet.

Norge har bygget den største flytende utstillingen til dags dato. Den har fått navnet Salmon Eye, og ligger nord for Kvinnherad kommune i Hardangerfjorden, den nest lengste fjorden i Norge. Med rekordstor størrelse ble den vakre strukturen designet og konstruert for å gi inspirasjon, utdanning og erfaring om bærekraftig fiskeoppdrett. Gjestene ble tatt med på en båt for å se avdukingen som ble etterfulgt av en rundebordsdiskusjon etterpå. Det er Eide-familiens håp at dette nye anlegget vil gi en bærekraftig form for fiskeoppdrett til verden.
Den 2. September 2022 ble Lakseøyet avduket for massene både fysisk og digitalt gjennom en direktesendt strømming klokken 12:15 (CET). Med Norge som den nest største sjømateksportøren i verden, først og fremst av laks, har konsernsjef for Eide Fjordbruk, Sondre Eide og Eide-familien utviklet, initiert og finansiert hele Lakseøyet.
Som en del av Eide Fjordbruks divisjon for Watermoonteknologi, er målet for Salmon Eye å forbedre sjømatnæringen og å bidra til å finne måter å øke produksjonen på, samtidig som man holder seg så bærekraftig som mulig. Med en økning i befolkningen på anslagsvis to milliarder innen 2050 anslår FN at en nødvendig økning i matproduksjonen på 56 prosent vil være nødvendig. For å nå Paris-avtalens mål er imidlertid Salmon Eye et forsøk på å bekjempe klimaendringer og redusere globale karbonutslipp i oppdrettsnæringen.
– Vi står overfor store utfordringer globalt, men svaret er ikke å gi opp. Svaret er å rulle opp ermene, arbeide sammen for å få
jobben gjort, og sørge for at verden blir brødfødd og blir et bedre sted i morgen enn det er i dag, sier Sondre Eide. Med det største kabuki-slippet som noensinne er gjort til sjøs, vil Salmon Eye forklare havbruks fotavtrykk, inspirere til oppdagelse og kreativitet globalt og vise frem innovative løsninger for bærekraftig marin matproduksjon for bedre å mate planeten.
Bærekraftig oppdrett
Salmon Eye er den håpefulle inspirasjonen for andre oppdrettere for å oppmuntre dem til å følge i Eide Fjordbruks fotspor. Forskere, ledet av Erlend Eide (Sondres bror), har utviklet ny teknologi og skal snart kjøre igang et storstilt pilotanlegg som gjør det mulig å oppdrette fisk i lukkede anlegg under overflaten. Visjonen for denne teknologien er at den skal bli for den globale matproduksjonsindustrien hva Tesla er for el-bilindustrien.
«Innovasjonene for fremtiden stopper ikke med Watermoons innovasjoner, og derfor trenger vi et sted som Salmon Eye for å presse industrien, myndighetene og frivillige organisasjoner enda lenger,» sier Sondre Eide.



Ved avdukingen ble det annonsert at det var positive resultater fra testene som ble utført av Watermoons pilotanlegg i lukket oppdrettsanlegg. Disse resultatene var revolusjonerende for oppdrettsnæringen, samtidig som de har produsert null negativ innvirkning på det marine miljøet.
Disse positive funnene inkluderer at de eliminerte lusproblemet for fisk, optimalisert fiskevelferdsmiljø og fiskevekst, redusert
behovet for energibruk versus landbasert oppdrett, og fjerning av avfall for prosessering på land.

Eide Fjordbruk sin innovasjon har som mål å være et stort skritt i retning av å oppnå det FN nylig har krevd i sin rapport om bærekraftig sjømat og Paris-klimaavtalen.
Målene som FN har satt for befolkningsøkningen, kan nå oppfylles med denne nye teknologien, mens klimafotavtrykket er dramatisk redusert og den negative virkningen på naturen fjernes.
Sebastian Torjusen tiltrådte stillingen som administrerende direktør for Salmon Eye i oktober 2020, jobbet med det danske firmaet Kvorning Design & Communications og det estiske konglomeratet Marketex Marine for å designe og utvikle Salmon Eye.
Strukturen er 14.55 meter høy på fire nivåer (over og under vann); 1000.6 kvadratmeter; veier 1 256 tonn; flyter ved en dybde på minst 250 meter og tåler fire meter høye bølger.
Torjussen sier om bygningen at: «Det har vært både veldig fint og svært krevende. Dette er et prosjekt som ingen har gjort før. Ingen har sett noe lignende før, så vi må gjøre mange ting for første gang. Det er både givende og vanskelig. Men jeg er sikker på at det vil gi oss et kult resultat som vi og forhåpentligvis publikum vil bli fornøyd med.»
Med utseende som på et «lakseøye» (derav navnet), ble strukturen bygget ved hjelp av 9250 ‘skjell’, hver av dem produsert av Marketex Marine i Tallinn, Estland. Tiden fra den første stålplaten ble kuttet til Salmon Eye var fullt utstyrt tok 13 måneder.
– Det har vært flere utfordringer underveis knyttet til produksjon av en dobbeltbuet ellipsoidestruktur som dette. I
kombinasjon med mange buede og ikke-standard løsninger har prosjektet krevet mye spesialarbeid, sier Torjussen.
Eide-familien finansierte hele konstruksjonen av Salmon Eye i den hensikt å bli en ideell organisasjon. Planen er at den skal være uavhengig og selvstendig styrt av et rådgivende styre, som inkluderer representanter fra miljøbevegelse, myndigheter, uavhengige forskere og eksperter.
Etter avdukingen ble det avholdt en rundebordsdiskusjon med deltakere fra regjeringen, interne organisasjoner, verdensledende forskningsinstitusjoner og mer. Blant foredragsholderne var Norges fiskeriminister Bjørnar Skjæran og statssekretær i Klimaog miljødepartementet, Sigrid Gagerup Melhus.
Andre foredragsholdere inkluderte Tom Rivett-Carnac, en av hovedarkitektene bak Paris-avtalen og medgrunnlegger av Global Optimism, en organisasjon han grunnla sammen med Christina Figueres etter at de forlot FN sammen i 2016; og Scott Lindell, spesialist i marin oppdrettsforskning ved MIT/Woods Hole Oceanographic Institution i USA.


Eide Fjordbruk er verdensledende innen bærekraftig sjømatproduksjon, og er et fiskeriselskap gjennom tre generasjoner. Nåværende administrerende direktør Sondre Eide overtok sjefsstolen i en alder av 28 år da hans far Knut Frode Eide døde av kreft. På den tiden hadde Sondre en MBA samt juridisk eksamen og hadde vunnet en sølvmedalje fra VM i skiskyting for juniorer.

Han og hans far har et ordtak: «Vi slutter aldri å løpe før oppgaven er fullført.» Nå har 32-år gamle Sondre sammen med sin bror Erlend jobbet for å forbedre selskapet og oppdrettsnæringen.
De ble det første selskapet til ikke bare å presentere miljøregnskap for virksomheten, men er også det første som produserer karbonnøytral laks. De har i tillegg redusert sine klimagassutslipp, redusert den negative effekten selskapet har hatt på natur og miljø, og bruker AI og moderne teknologi for å sikre bedre fiskevelferd.

For å lese mer om dette prosjektet, gå til: https://aqfeed. info/e/1592











Etter å ha gjennomgått fem år med intens forskning og utvikling innen rekeoppdrett, er Local Ocean mye nærmere å utvikle en unik maskinvare og programvarepakke for rekeoppdrett. Ved å slå sammen og tilpasse rimelige rekeproduksjonsmetoder fra utendørs damoppdrett og innendørs RAS (resirkulerende akvakultursystem) vil oppdrettsteknologi for fiskeoppdrett, en fullstendig bærekraftig, lavkostnads-, høyavkastningsrekeproduksjonsløsning på et lite fotavtrykk, bli opprettet.
For tiden er man på TRL6-stadiet av utviklingen, og pakken vil være klar til å bli lisensiert til andre rekeoppdrettere innen to år når den er fullt utviklet og stress-testet. Prototyper er allerede operative og produserer reker for levering til det litauiske innenlandsmarkedet via supermarkedskjedene Maxima og Rimi og også til HoRecA-distributør Bidfood.
Local Oceans maskinvare har en unik multi-tank arkitektur spesielt utviklet for rekenes vekst-akselerasjon og styres av sin skreddersydde programvare som kontrollerer og kontinuerlig optimaliserer vekstprosessen ved hjelp av AI;
forretningsprosesser og vann-kjemikalieparametere for å etterligne vannet i Stillehavet.
For tiden støtter Local Ocean-systemet produksjon av 130 kg reker i måneden (med en FCR på 1.8:1) over et 40 m2 fotavtrykk og bruker bare 3KwH elektrisitet og setter seg et mål på 200 kg reker per måned med samme fotavtrykk.
Resultatet vil bli oppnådd ved å øke overlevelsesraten (for tiden på 50%) gjennom en mer raffinert styring av prosessen, men også ved å samarbeide med andre involverte parter, som klekkerier, for å utvikle bedre genetikk, og også fôrprodusenter for å øke vekstraten, vannstabilitet og redusere FCR i Local Oceans systemer.
I utgangspunktet var Local Ocean et selskap designet for å være en rekefarm, men det ble klart at Local Ocean alene ikke ville være i stand til å møte den europeiske etterspørselen av de 400 000 tonn som importeres fra Asia og konsumeres hvert år, og med programvare- og teknologi-bakgrunnen til grunnleggerne (ikke marinbiologi), har Local Ocean utviklet en forutsigbar teknologipakke som er enkel å administrere for å hjelpe andre oppdrettere til å oppdrette reker mer effektivt i alle typer

lokaliteter, gjennom lisensiering av sin teknologi.
Det frittstående systemet er enkelt å installere i alle typer bygninger og krever ikke avansert ingeniørarbeid: Det er plug-and-play. Så enten du har et 1 000m2 eller et 50 000 m2 rekeoppdrettsanlegg, er det eneste som endrer seg det antall frittstående enheter du kan plassere i det rommet!
Ved å alltid ha det samme standardiserte produktet i drift, kan du også alltid forvente de samme resultatene. Local Oceans kunder som har installert maskinvare vil styre sitt autonome anlegg ved hjelp av programvaren som forteller dem hvilke operasjoner som må utføres for å holde vann og reker i optimal
stand.
Dette er ikke nødvendig å ha en universitetsutdannelse i akvakultur: All vannkjemisk balanseringsberegning, fôrprotokolltilpasning i henhold til vannstatus eller vekststadiet beregnes kontinuerlig av programvaren, og operatøren ser bare «å gjøre»-listen! Dette vil redusere potensielle feil fra operatører samt spare verdifull driftstid.

produksjonsstabilitet
Local Ocean har som en sentral oppgave til hensikt å drive forskning og utvikling for å forbedre avkastning, produksjonsstabilitet og fôringsprotokoller fra systemet og vil bruke sin sky-baserte programvare-arkitektur til automatisk å
oppgradere sine klienters oppdrettsprotokoll i sanntid til fordel for sin egen virksomhet.
Det er ingen hemmelighet at tradisjonelt utendørs rekeoppdrett er svært ødeleggende for miljøet med rundt 700 000 fotballbaner med mangrover, et av de mest miljøvennlige systemene på planeten, har blitt bulldoset i løpet av de siste 30 årene for å gjøre plass til rekedammer. Det har vært på Greenpeace sin røde liste i over 20 år for miljøsystem-ødeleggelse, misbruk av menneskelig arbeidskraft og vannforurensning.
Men den verste lovbryteren er fortsatt det ville rekefisket som bruker bunntrål. Denne metoden å fiske reker på resulterer i den verste bifangsten i globale fiskerier med totalt ca 30 prosent
Reketråling har et bifangstforhold på 5.7:1, noe som betyr at for hver kilo reker fanget, fanges 5,7 kg andre marine arter (for det meste uegnet til menneskelig konsum) også.
Reker er en stor business med en global produksjon på 4.7 millioner tonn per år og en total verdi på 45 milliarder dollar. Denne virksomheten er her for å bli og står faktisk overfor en økende etterspørsel (5% per år) fordi reker er en utmerket kilde til proteiner og for tiden et billig produkt å oppdrette på grunn av dagens hovedsaklig uregulerte produksjonsmetoder.
Local Ocean har til hensikt å endre denne industrien ved å tillate innendørs rekeoppdrett hvor som helst gjennom lisensiering av teknologien til rekeoppdrettsprosjekter.
Innendørs rekeoppdrett betyr at produktene blir produsert nær forbrukerne, hvilket reduserer import-avhengighet samt muligheten til å levere produktet ferskt i stedet for frosset og sendt fra den andre siden av verden.
Metoden til Local Ocean kommer også med null kjemisk avfall og null avfall som standard, da vannet den bruker blir gjenbrukt i nye sykluser, og slamavfallet forvandles til biogass og gjødsel også. En virkelig nyhet for bransjen.
Det er ikke rart da at Local Ocean-prosjektet har fått politisk støtte fra Ministry of Agriculture og fra Ministry of Economy and Innovation of the Republic of Lithuania, har deltatt i Blue Invest- og Invest Horizon-akseleratorprogrammene finansiert av EU i 2021, og kom på 2022-listen over de 50 beste oppstartene for klimaendringer i Sentral- og Øst-Europa.
Local Ocean blir nå med i Blue Bio Value-programmet og CIVTech Alliance for å øke rekkevidden ytterligere. Men ikke alt er perfekt, ettersom alle langsiktige forpliktelser til å endre det vi putter i munnen gjør det nødvendig med mye investering før man sitter med sluttproduktet.

Tenk på at innendørs rekeindustri i dag er som var lakseoppdrett var for 20 år siden. Europeisk rekeoppdrett er langt unna å nå kritisk størrelse! Ved hjelp av Local Ocean systemet i sitt nåværende utviklingsstadium ville det kreve bygging av ca 800 oppdrettsanlegg på 20,000 m2 i Europa, hver kjører rundt 300 av sine systemer for å erstatte sin årlige import av lokalt produserte reker.
Local Ocean er godt plassert for å få ytterligere finansiering fra ulike EU-programmer, men trenger fortsatt privat kapital for å utnytte EUs innsats for å støtte det Local Ocean gjør.
Local Ocean har behov for økonomisk støtte fra organisasjoner og enkeltpersoner som ønsker å endre verden til det bedre, og som kan vente syv til ti år før de ser de fantastiske utsiktene for utvikling bli realisert og gjøre denne visjonen til virkelighet.
Så hvis du er interessert i å delta i dette prosjektet, ikke nøl med å kontakte meg (Christophe Legrand, CEO, Local Ocean) direkte på https://aqfeed.info/e/1591
Extruder AL300
Almex offers a wide range of single screw extruders and expanders which are used for different applications.
The robust and simple design of the Almex machines guarantees years of economical and trouble free production.
Scan the QR-Code for more information www.almex.nl

Oppdrettsnæringen taper anslagsvis 72 milliarder dollar på grunn av sykdom og vannkvalitetsproblemer årlig. Rekeoppdrettere lider rutinemessig tap på 50%, 75%, og noen ganger til og med 100% av sin biomasse på grunn av patogen-utbrudd alene.
Dette er ikke bare en komplett wipeout av en oppdretters levebrød, men også tap av en sikker proteinkilde for hundrevis, om ikke tusenvis av mennesker. Når en oppdretter mister rekene sine på grunn av sykdom, er det ikke bare et tap for ham, men også for menneskeheten.
Etter hvert som verdens befolkning vokser, vil presset på akvakultur for å møte våre proteinbehov bare øke. Men pandemien forårsaket globale forstyrrelser i hele forsyningskjeden, og har bare forsterket dette trykket.
Sammen med sykdomsutbrudd har denne typen problemer utløst alarm på steder som India, hvor sjefen for CP har påpekt et presserende behov for innovasjon.
eller
Når sykdommen tar tak, kan det være både frustrerende og ødeleggende (for ikke å nevne dyrt). Ofte ser sykdommen ut til å komme ut ingensteds, med lite eller ingen advarsel. Som i tilfelle med patogenutbrudd, når du ser lesjoner eller White Spot, er det altfor sent å hindre problemet, og operasjonen må gå over til
forsvarsstrategier, prøve å redusere tapet så mye som mulig og redde hva man kan.
Men patogenutbrudd ikke bare skjer. Patogener er listige opportunister, alltid til stede i lave, ufarlige antall, liggende på vent på de riktige forholdene slik at de kan gå over i spredningsmodus. Disse ‘riktige forholdene’ kan omfatte et fall i oksygenmetning, kjemi-ubalanser, akkumulering av ammoniakk, nitritter eller faste stoffer som oppløst organisk materiale.
Men uavhengig av de mange forskjellige faktorene som kan utløse et utbrudd, vil det alltid være en bombesikker hendelse som må oppstå og nesten garanterer et patogenutbrudd: En dødelig forstyrrelse i mikrobiommiljøet. Når mikrobiomet tipper over til det som kalles en dysbiotisk tilstand, eller en ubalansert tilstand, skapes et tomrom. Og som den gamle ordtaket sier: Naturen hater et vakuum.



Patogener er overalt, og de er her for å bli.
– Vi har sekvensert hundrevis om ikke tusenvis av prøver fra det åpne havet, til uberørte korallatoller, til tanker og dammer over hele verden, og vi har aldri sett et utvalg som var patogenfritt, sier Rachelle Jensen, administrerende direktør i Luminis Water Technologies.
Etter to års kamp mot den globale pandemien, kommer både regjeringer og publikum endelig til
den konklusjon at null Covid er umulig. Covid er her for å bli, og nå må vi finne ut hvordan vi best kan håndtere det.
Patogenforvaltning i akvakultur kan betraktes mye på samme måte. Patogener er her for å bli. Vi må lære å effektivt håndtere dem slik at de sjelden, om noen gang, blir gitt muligheten til å vokse.
Utfordringen er vanskelig fordi både gode og dårlige krefter i kampen om vannhelsen begge er bakterielle. Behandling av vann med antibiotika for å bekjempe patogener dreper også de gunstige bakteriene som er kritisk nødvendige for vannkvalitet og fiskehelse. Mens behandlingen oppnår en reduksjon i patogenbelastningen, dreper de også sine sterkeste allierte. Luminis foreslår et annet paradigme når det gjelder patogenhåndtering: Utnytt kraften i mikrobiomanalyse.
I en dråpe vann er det millioner av mikrober som danner selve grunnlaget for helse i alle akvatiske miljøer, inkludert tanker og dammer. Dette fellesskapet av mikrober inkluderer mange gode bakterier, noen dårlige bakterier, alger, gjær, diatomer, virus, mikroorganismer og mye mer. I likhet med det menneskelige tarmmikrobiomet, fungerer disse usynlige livsformene sammen for å underbygge helse og velvære for både vann og fisk.
Tenk på mikrobiomet som en kompleks matrise som danner et usynlig slør mellom fisk og patogener. Når denne matrisen oppfordres til å trives, fungerer den som en barriere for patogenvekst, samtidig som den tar vare på viktige tjenester som vannkvalitet og forbedrer veksten og appetitten hos fisken.
Når denne matrisen av mikrober er destabilisert eller drept, er patogener gitt et ‘Get Out of Jail Free’-kort, og de kaster ikke bort tiden på å dra nytte av de nye forholdene.
Hemmeligheten bak sykdomsforebygging er å fremme tilstander som oppmuntrer til gunstig bakterievekst ved å sette sammen probiotika og NOB og AOB (nitritt og ammoniakk oksiderende bakterier) på en riktig måte, opprettholde systemkjemi, maksimere bæreevne og overvåke fatale sammenbrudd i mikrobiomet. Next Gen Microbiome Analytics gjør det mulig å oppdage ubalanser i systemet og ta skritt for å rehabilitere mikrobiomet før det er for sent.
«Bæreevnen i en dam er viktigere i oppvekstfasen enn teknikk eller teknologi. Damhelsen er 80 prosent, og rekeoppdretteren 20 prosent, sier Dr. Sharma.
Dette er en forbløffende observasjon fordi etter hvert som bæreevnen øker, øker sjansen for en dødelig sammenbrudd i mikrobiomet også.
Røntgensyn for vann
«Bruken av ny teknologi basert på Next Gen-sekvensering, AI og IOT er fremtiden for akvakultur», sier Dr. Giana Gomes, leder for marin bioteknologi i Temasek Life Sciences.

Neste generasjons sekvensering
og analyse tilbyr mer enn bare kjent eller ukjent patogen ID. Ved å utnytte kraften i mikrobiomanalyser kan fiske- og rekeoppdretterne utnytte et avgjørende mulighetsvindu som ligger mellom ubalanser og en omfattende sykdomshendelse.
Men kanskje den viktigste fordelen er evnen til å ta informerte, målrettede beslutninger som kan føre til reduserte driftskostnader og økt avkastning.
Neste generasjons øyeblikksbilder av helse
Ikke bare kan analyser gi et avgjørende mulighetsvindu når det gjelder å spare fisken for sykdomsutbrudd, Luminis Water Technologies tilbyr også enestående «øyeblikksbilder av helse». Utvalget av AquaGENius mikrobiom-feltprøvetakingssett er enkelt og brukervennlig. Operasjonen kan teste vann, innvoller, lesjoner, biofilm, og finne parasitter i vannet gjennom miljøDNA-settet. Når prøvene er sendt tilbake til Luminis sitt sekvenseringslaboratorium, gjennomgår de neste generasjons sekvensering og datamatching gjennom Luminis sin proprietære database som matcher sekvenser ned til artsnivå.
AquaGENius gir innsikt i syv viktige områder: mikrobiomubalanser, patogener, cyanobakterier, alger, biologisk mangfold, probiotika, og biofilter bakterier.
Andre bruksområder inkluderer: Screening av i fisk i karantene for å indetifisere parasitter og skadedyr som igler, spore effektiviteten til fôr og probiotika, identifisere årsaker som fører til redusert vannkvalitet, og verifisere om en behandling faktisk drepte alle patogener eller bare redusere belastningen.
Å identifisere «hvem» som er i enhver prøve og «hva» de gjør, fører til bedre, mer presise og målrettede beslutningsprosesser, noe som til slutt fører til smartere og mer bærekraftig bruk av vannressurser.
Luminis Water Technologies er dedikert til å tilby datadrevne og gjennomførbare løsninger som vil bidra til å takle noen av de mest presserende problemene innen vannforvaltning og oppdrettsnæringen i dag.
Om Luminis Water Technologies Det Singapore-baserte teknologiselskapet Luminis Water Technologies søker å ta akvakulturnæringen til et nytt nivå av effektivitet ved å tilby en rekke Next Gen mikrobiome analytiske løsninger.

I denne månedens produktpresentasjoner tar vi tak i vannkvalitet i akvakultur, noe som er spesielt viktig i RAS-anlegg, inkludert et avløpssystem, et smart overvåkingssystem og et UV-desinfeksjonssystem, for å forbedre vannkvaliteten i fiskeoppdrett. Hvis du ønsker at produktet eller tjenesten din skal tas med i denne delen i en fremtidig utgave av tidsskriftet International Aquafeed and Fish Farming Technology, kan du kontakte oss på editorial@perendale.co.uk
Faivre Helios 40 fiskesortering
Ved å kombinere stor nøyaktighet og høy hastighet i sortering med en rimelig pris, er Helios 40 fra Faivre en sorterer spesielt produsert og designet av Faivre for å møte kravene til oppdrettere. I tillegg til sin kapasitet til å sortere både ørret og laks fra 10 g til 1 kg, har Helios 40 tre sorteringskanaler, med en sorteringskapasitet på 25,000 fisk som veier 200 g per time. De viktigste fordelene inkluderer en sorterermontering med SPSteknologi for høyhastighets sortering uten skade, den er laget av høykvalitets AISI 304L eller 316L rustfritt stål (sjøvann), enkel justering på grunn av en løftejekk og et vanningssystem utstyrt med justerbare porter. www.faivre.fr aqfeed.info/e/1601
SmartEye Modular fra AKVA Group SmartEye Modular er et avansert, dobbelt fôrings-- og inspeksjonskamera som gir operatøren bilder av HD-kvalitet. Den fungerer som et lysfølsomt kamera og kjører skreddersydd software for å optimalisere driften i et undervannsmiljø, med en 360° visning av merden. På denne måten leverer den høykvalitets undervannsvideobilder selv når du filmer i dype og mørke merder. Det modulære kamerasystemet SmartEye er fullt konfigurerbart for å dekke operatørens nåværende og fremtidige behov. Det har brukervennlig programvare kombinert med robust trådløs videooverføring.
Kameraet leveres med innebygde dybde- og temperatursensorer som kan kombineres med et av vinsjsystemene.
Andre bemerkelsesverdige funksjoner er den robuste designen, den automatisk justerte fargebalansen og en ny lysmodul som kan legges til for å se i selv de mørkeste og dypeste omgivelser.
www.akvagroup.com


AQ-serien fra ANB Sensors
ANB Sensors tilbyr en rekke pH-sensorer av varierende størrelse og spesifikasjoner for overvåking av havet og vannområder. Ved hjelp av ANBs patenterte teknologi er sensorene kalibreringsfrie og mekanisk robuste og kan oppbevares vått eller tørt, noe som krever minimal brukermedvirkning.
Dagens hav pH-sensorer bruker optiske sensorer som bruker en rekke teknologier og som er store, dyre, eller krever årlige rekalibreringer og korreksjoner for dybde og saltholdighet. ANBs sensorer unngår alt dette.
For tiden har selskapet OC-serien og AQ-serien, med sistnevnte utviklet spesielt for overvåking av akvakultur i ferskvann.
Funksjonene i AQ-serien inkluderer lite vedlikehold, enkel lagring, rask og enkel autostart-måling og innebygd temperaturmåling. Ytterligere funksjoner inkluderer et pH-område på 2–10, driftstemperatur på -5–40 °C og strømforbruk på 110mA. www.anbsensors.com



Små kompressorer fra Kaeser
Kaeser Compressors sine små kompressorer er allsidige, pålitelige og enkle å transportere, de tar minimalt med plass, og er utstyrt med høykvalitets motorer og støtsikre PE-kabinetter, klare for alt.


De små kompressorene kan håndtere maksimalt trykk fra 7 til 15 bar. 15-bar-versjonen er godt egnet for grøftefri legging av fiberoptiske kabler.

Fordelene inkluderer rask distribusjon til enhver lokalitet, da de små kompressorene veier ca. 200 kg og derfor er enkle å laste, gir brukervennlige kontroller og er intuitive å betjene, og rotasjonssentrert PE-kabinetter som gir optimal støy- og støtbeskyttelse.
Serien leveres også med elektriske motorer som kan håndtere trykk opp til 15 bar. Fordelene ved å bruke de miljøvennlige modellene er at de fungerer godt i miljøer der det er behov for stille og eksosfrie forhold.
www.kaeser.co aqfeed.info/e/1602
www.onlinemillingschool.com
Med over 35 års erfaring innen akvakultur kommer RiaWatech med et nytt produkt, Ria Flow Guide 3-veis ventil. Den er enkel å installere og manøvrere, og radiusen til svingen i kjernen er utformet for å redusere skade på fisken, og HDPE-leppen har optimalisert tykkelse for trykk i RAS. Den har en mekanisk posisjonsindikator,

slik at operatøren kan se kjernens posisjon og unngå feiljustering med et rustfritt presisjonskamera som sikrer korrekt avlesning.
Ventilen er designet med avrundede indre kanter og er laget for å redusere skade på fisken, noe som fører til større produksjon og mer lønnsomhet for oppdretteren. Den leveres med støttebraketter med løfteøyne og ben med festeplater, noe som sikrer en rask og enkel installasjon og reduserer kostnadene.
https://riawatech.dk
RIA Flow Guide 3-veis ventil fra RiaWatechTesting av levedyktigheten til erteprotein og tang som nye proteinkilder
Av Alicia Estévez, forsker, Institute of Agriculture Research and Technology (IRTA), San Carlos de la Rápita, Tarragona, Spania & Phelly Vasilaki, Irida sa, FoU Management, Nea Artaki Evia, Hellas
På grunn av den begrensede etterspørselen fra markedet og de tekniske vanskelighetene i produksjonen, har ikke produksjonen av økologisk fisk økt. Flere barrierer knyttet til problemer med å overholde EU-forskriftene (EU 2018/848) når det gjelder dyrevelferd er identifisert av interessenter.
Disse barrierene omfatter separasjon av organisk produksjon fra konvensjonell produksjon, tilgjengelighet og høye kostnader for organisk fôr, tilgjengelighet av økologisk sertifisert yngel, forvaltning av parasitter og bruk av lavere fisketetthet i organisk enn i konvensjonelt oppdrett, hvilket førte til høyere produksjonskostnader som ikke kompenseres av en høyere prisen.
Forbedring av rollen til organiske produkter Europakommisjonen publiserte (2021) en handlingsplan for å akselerere utviklingen av den organiske sektoren. Planen tar sikte på å øke produksjonen og forbruket av økologiske produkter, for å nå 25 prosent av landarealet i økologisk landbruk innen 2030, samt en betydelig økning i økologisk akvakultur, som er
Ifølge EUMOFA (2022) nådde den totale produksjonen av økologisk akvakultur i EU 74 032 tonn i 2020 (6.4 % av den totale produksjonen av akvakultur i EU), med blåskjell som den viktigste arten som produseres (41 936 tonn) etterfulgt av laks (12 870 tonn), ørret (4 590 tonn), Karpe (3 562 tonn), østers (3 228 tonn) og europeiske seabass/gilthead seabream (2 750 tonn).
målsetningen i EUs Farm to Fork and Biodiversity Strategies. Planen er strukturert rundt 23 tiltak, og gir sektoren de riktige verktøyene og forbedrer organisasjonens rolle i kampen mot klimaendringer og bærekraftig ressursforvaltning, noe som bidrar til sunnere og biologiske økosystemer.
Tabell 1: Formulering (% inkludering) og FM/FO-forhold av fôrene som brukes i oppvekst av regnbueørret og gilthead seabream under organiske forhold. Regnbueørret Gilthead Sea Bream

Ingredienser (%) CTRL PEA 10% PEA 21.5% CTRL PEA 8.5% PEA 19%
FM fra avskjær 47.5 33.0 19.0 51.3 38.5 25.6
Økologisk soyabønnemel 24.0 24.0 24.0 25.2 25.2 25.2
FO fra avskjær 14.3 15.0 15.6 8.7 9.4 10.0 Økologisk hvete 13.7 12.1 12.4 14.4 11.0 12.8 Økologisk erteprotein - 10.0 21.5 - 8.5 19.0 Organisk gjær - 5.0 5.0 - 5.0 5.0 Tang - - - - 2.0 2.0 Organisk premix (vit + min) 0.25 0.25 0.25 0.25 0.25 0.25 Kolin 50% 0.15 0.15 0.15 0.15 0.15 0.15 Naturlig antioksidant 0.03 0.03 0.03 0.03 0.03 0.03
Monosodiumfosfat - 0.7 1.95 - - -
FM/FO 47.5/14.3 33.0/15.0 19.0/15.6 51.3/8.7 38.5/9.4 25.6/10.0
Handlingsplanen for utviklingen av den organiske sektoren legger frem aktiviteter strukturert rundt tre tiltak:
1. Øke forbruket samtidig som forbrukernes tillit opprettholdes
2. Øke produksjonen
3. Forbedre bærekraften i sektoren enda mer
For å forbedre den organiske marine fiskeproduksjonen, er det derfor nødvendig med proteinkilder som bidrar til å redusere produksjonskostnadene uten å redusere vekst og fiskens fôrutnyttelse, og å sikre et kvalitetsprodukt ved slutten av oppvekstfasen.
Redusere mengden av fiskemel
IRTA og Irida har gjennomført en test som en del av New Tech Aqua Project (H2020, Project 862658), for å studere bruken av et sertifisert økologisk erteprotein og tang som nye ingredienser for den voksende økologiske regnbueørret og seabream. Fôret ble formulert og utarbeidet av Irida ved hjelp av to forskjellige inklusjonsnivåer av erteprotein, samtidig som mengden fiskemel ble redusert (tabell 1).
De eksperimentelle diettene ble fôret til juvenil regnbueørret (60g) og gilthead seabream (145g) to ganger daglig i en periode på 60 dager da fôrmengden som ble gitt ble kontrollert for å beregne fôrfaktoren. Fisken ble i prøveperioden holdt i de forhold som er angitt i EU2018/848-forskriften, i.e. åpent strømningssystem, ingen oksygentilsetning, lav tetthet (maks. 25 kg per m3).
Ved slutten av prøveperioden ble all fisk veid for å beregne relativ vekst (RGR, %) og spesifikk vekst (SGR). Fem fisk per tank ble ofret og leveren og involler dissekert for å beregne viscerosomatiske (VSI) og hepatosomatiske (HSI) indekser. Prøver av ryggmuskelen og leveren ble brukt til biokjemisk
og filetutbytte (%) av gilthead seabream fôret med eksperimentelle dietter inkludert organisk erteprotein på 8.5 og 19% inkludering. Forskjellige bokstaver indikerer betydelige forskjeller. Sea Bream SGR RGR FCR HSI VSI Filetutbytte
SD Av SD Av SD Av SD Av SD Av SD CTRL A 0,68 0,05 a 53,08 4,34 a 2,58 0,26 2,13 1,26 8,44 4,13 29,63 12,96 ERT 8.5% B 0,62 0,05 b 47,45 4,68 b 2,79 0,34 2,74 1,25 10,75 5,22 32,90 15,64 ERT19% C 0,59 0,00 b 45,35 0,42 b 3,05 0,82 2,51 1,50 10,74 5,40 32,67 15,60

ANOVA P<0.001 <0.001 0.19 0.623 0.532 0.873
Tabell 3: Vekstindekser (SGR: Spesifikk vekstrate, RGR: Relativ vekst) fôr-konverteringsfrekvens (FCR), noentiske indekser (HSI: Hepatosomatisk, VSI: Viscerosomatisk) og filetutbytte (%) av regnbueørret fôret med eksperimentelle dietter inkludert organisk erteprotein på 10 og 21.5% inkludering. Forskjellige bokstaver indikerer betydelige forskjeller. Regnbueørret SGR RGR FCR HSI VSI Filetutbytte Av SD Av SD Av SD Av SD Av SD Av SD
CTRL A 1.81 0.115 a 68.48 2.362 a 1.31 0.12 b 1.37 0.18 12.49 1.65 b 25.29 1.77
PEA 10% B 1.75 0.025 a 67.34 0.526 a 1.18 0.03 c 1.43 0.32 13.07 2.26 b 25.89 1.89 ERT 21.5% C 1.62 0.071 b 64.57 1.637 b 1.98 0.14 a 1.65 0.32 16.33 1.57 a 25.07 2.17
ANOVA P<0.001 <0.001 <0.001 0.107 <0.001 0.659
Tabell 4: Protein- og lipidinnhold (% tørrvekt) av regnbueørret og gilthead-seabream-filet ved slutten av fôringsforsøket. REGNBUEØRRETFILET GILTHEAD SEABREAM FILET
KONTROLL 10% ORGANISK ERT
21.5% ORGANISK ERT
KONTROLL 8.5% ORGANISK ERT
19% ORGANISK ERT Av SD Av SD Av SD Av SD Av SD Av SD
Vann (% ) 70,92 0,32 71,99 0,07 73,18 0,34 71,38 0,35 71,90 0,29 72,45 0,18 Protein (%) 60,25 1,04 59,89 0,89 66,71 3,89 59,17 2,22 62,97 3,93 70,26 1,78 Lipider (%) 12,81 0,25 12,88 0,54 10,87 0,48 12,01 0,17 10,61 0,07 8,37 0,11
analyse: Protein- og lipidinnhold og fettsyreprofil.
I begge studiene viste fisk som var fôret med kontrolldietten den høyeste veksthastigheten både når det gjelder SGR og RGR. I regnbueørret viste fisken en ikke-statistisk annen vekstrate sammenlignet med kontrollgruppen.
For seabass (tabell 2) viste alle indeksene (somatisk og fôrkonvertering) ingen forskjeller mellom fôrene, mens det for regnbueørret (tabell 3) ble oppnådd den beste fôrfaktoren med fôret som inneholder 10 prosent organisk erteprotein, mens fisken fôret med 21.5 prosent erteprotein viste den høyeste VSI, hvilket indikerer en høyere perivisceral fettakkumulering.
Sammensetningen av fileten (tabell 4) i begge artene viste
et høyere proteininnhold når fisken ble fôret med høyest inklusjonsnivå av erteprotein, var lipider også lavest i fisken som ble föret med høyest innhold av erteprotein.
Fettsyresammensetningen i regnbueørret viste at lav inkludering av erteprotein (10 %) i fôret produserte fisk med lignende sammensetning som kontrollen både i filet og leveren.
For seabass viste fisken som ble fôret med det laveste erteproteinet (8.5 %) den høyeste dokosaheksaensyre (DHA) og totalt omega-3 fettsyreinnhold i fileten, mens leveren viste det høyeste innholdet av omega-6 og mono-umettede fettsyrer som reflekterer fettsyresammensetningen av fôret.

Lignende vekstrater
Som konklusjon: inkludering av sertifisert organisk erteprotein alene eller sammen med tangprotein produserte en vekst som ligner den som oppnås ved hjelp av et kommersielt organisk fôr som brukes som kontroll. Fôrkonvertering hos begge arter, både ørret og seabass, var også lik den som ble oppnådd for kontrollgruppen, spesielt ved bruk av lavere inkludering av erteprotein.
Den endelige produktkvaliteten i form av både protein og fettsyreinnhold var også svært høy og sunn, noe som gir en merverdi til fisken i markedet. Reduksjonen av inklusjonsnivåene av fiskeavskjær vil også bidra til å redusere de høye nivåene av fosfor og redusere kostnadene for fôrene.
EUMOFA. 2022. Økologisk akvakultur i EU. Nåværende situasjon, drivere, barrierer, potensial for vekst, 48 sider. WWW.EUMOFA.EU
Europakommisjonen. 2021. Ny handlingsplan vil øke økologisk landbruk og akvakultur i Europa. Generaldirektoratet for Maritime Affairs and Fisheries. https://oceans-and-fisheries.ec.europa. eu/news/new-action-plan-will-boost-organicagriculture-and-aquaculture-europe-2021-03-25_en
Alle referanser er tilgjengelig på forespørsel
The Packaging Group GmbH Gerberstraße 50 · 51789 Lindlar, Germany · www.the-packaging-group.com













































Statusoppdateringer for bransjearrangementer i lys av globale effekter av COVID-19
2022 September
1-3
Taiwan SmART Agriweek 2022 Taipei, Taiwan www.taiwanagriweek.com
6
Aquaculture Innovation Forum London, Storbritannia aquacultureinnovationforum.com
4-6
Fish International 2022 Bremen, Tyskland https://fishinternational.de

7-8
Seagriculture USA 2022 Portland, Maine, USA https://seagriculture-usa.com

13-15
SpACE 2022


Rennes i Frankrike http://uk.space.fr
22-23
Aquaculture New Zealand Conference 2022 Nelson, New Zealand www.aquaculture.org.nz
New Zealands Aquacultural Association, Aquacultural New Zealand, holder sin konferanse i 2022 fra 5-6. oktober på Rutherford Hotel i Nelson, New Zealand. Med fokus på innovativ teknologi og målrettet forskning for å bidra til å bygge elastisitet, forbedre ytelsen, fremme infrastruktur og styrke produktiviteten i bransjen, er New Zealand Aquaculture Conference allment anerkjent som New Zealands beste primærnæringskonferanse.




Covid-19 førte til at de to tidligere konferansene ble kansellert, kollokviet ville da bringe industrien og interessentene sammen for en to-dagers personlig samling full av inspirerende foredragsholdere, tankevekkende diskusjoner, enestående nettverksmuligheter.
I tillegg til dette har Aquaculture New Zealand Conference også som mål å ha flere diskusjoner om biosikkerhetspraksis, utvikle en blomstrende arbeidsstyrke og invitere til investering i Maori-stammer
27-30
Aquaculture Europe 2022 Rimini, Italia www.aquaeas.org
2022 Oktober 12-14
Vietstock 2022
Ho Chi Minh-byen, Vietnam www.vietstock.org
2022 November
3-5
Future Fish Eurasia Gaziemir – Tyrkia https://eurasiafairs.com
Den 10. Internasjonale messen for fiskeimport/eksport, prosessering, akvakultur og fiskeri ,Future Fish Eurasia, blir organisert fra 3-5 november, 2022, på Fair Izmir Center, Tyrkia.

På dette arrangementet, som er organisert av Eurasia Trade Fairs, vil over 200 lokale og internasjonale produsenter i bransjen vise sine nyeste produkter og tjenester innen sjømatprodukter, akvakultur, fiskeforedling og fiskeutstyr.
Som Tyrkias eneste messe for industrien og det ledende arrangementet i regionen, er Future Fish Eurasia inngangsporten til nye / fremvoksende markeder. Den dynamiske strukturen i tyrkisk akvakultur og Future Fish Eurasia danner en perfekt plattform for de som er i sjømatnæringenn.
Dette showet vil gi en mulighet til å introdusere oppdretts- og / eller prosesseringsteknologi til Tyrkia og nabolandene, og også kjøpe høykvalitets sjømatprodukter eller selge alternativ sjømat.
9-11
AFIA Equipment manufacturers Conference 2022 St. Petersburg, Florida, USA www.afia.org
9-11
Ildex Indonesia 2022 Jakarta, Indonesia www.ildex-indonesia.com 15-18

EuroTier 2022 Hannover, Tyskland www.eurotier.com 29-2
World Aquaculture Singapore 2022 Singapore www.was.org

2022 Desember 13-15
AlgaEurope 2022 Roma, Italia https://algaeurope.org

Aquaculture America 2023 New Orleans, Louisiana, USA www.was.org 2023 mars 8-10
VIV Asia 2023
Nonthaburi i Thailand www.vivasia.nl 2023 mai 29-1
World Aquaculture 2023 Darwin i Australia www.was.org 2023 Juni 8-10
VIV Tyrkia Istanbul i Tyrkia www.vivturkey.com














Nor-Fishing 2022, en av de største fiskeriteknologimessene i verden, ble holdt i Trondheim i august 2022.

Dette var første gang siden 2018 at det ble holdt en fysisk utstilling. I 2020 valgte arrangøren, Nor-Fishing Foundation, å ha et rent digitalt arrangement, som var en stor suksess.
I kjølvannet av dette bestemte stiftelsens styre seg for å utvikle en ny hybrid plattform, som kulminerer i et tilbud som inkluderer en digital begivenhet, i tillegg til den gammeldagse fysiske utstillingen.
For å fastslå om dette nye formatet har blitt ansett som en suksess av arrangørene, snakket International Aquafeed nylig med Kristian Digre, administrerende direktør i stiftelsen.
Hva var de hensyn som lå til grunn for beslutningen om å gå over til en hybrid utstilling i stedet for bare en fysisk?
Grunnen til at vi kjørte det rent digitale arrangementet i 2020 var at vi følte det var viktig at vi faktisk var til stede. Vi var litt redd for at vi ville bli glemt. Vi hadde snakket om å utvikle en digital tjeneste en stund, men Covid-pandemien tvang oss til å fremskynde planene våre.
Faktisk hadde vi bare tre måneder på å utvikle den nye plattformen, men med hjelp av virkelig gode fagfolk klarte vi å få den klar i tide.
Hva ser du som fordelene ved å ha en digital tjeneste i tillegg til den tradisjonelle utstillingen?
Den digitale tjenesten gjør det mulig for oss å nå folk som av ulike grunner ikke kan komme til Trondheim til det fysiske arrangementet. Mange hadde problemer på grunn av Covidpandemien, selv i 2021, da vi holdt vår andre utstilling, Aqua Nor.
I 2021 fikk bare nordiske borgere lov til å reise inn i Norge, og vi har normalt rundt 70 – 75 nasjonaliteter på Aqua Norutstillingen. Men like viktig er det faktum at den digitale versjonen blir liggende på nettet og er tilgjengelig i et helt år etter at selve utstillingen er stengt.
Hva består hybridplattformen av?
Vårt konsept er ganske komplisert og inkluderer ikke bare den digitale utstillingen, der hver utstiller har en «hjemmeside» som kan besøkes. Besøkende kan også bestille én-til-én møter med utstillerne, og de kan følge en live stream, som under utstillingen går i fem timer hver dag.
I tillegg bruker vi ulike sosiale medier som Facebook, Instagram, LinkedIn, YouTube osv. for å nå ut til vårt publikum.
Det må kreve mange mennesker til å drive et slikt komplekst show?
Vi har bare to heltidsansatte, men vi har en rekke deltidshjelpere, og vi bruker profesjonelle TV-produsenter for live-strømmen og mye annen midlertidig teknisk og journalistisk hjelp.
Du har også et ganske stort profesjonelt program, med mange presentasjoner etc.
Ja, dette er noe vi har kunnet etablere ved hjelp av to vitenskapelige institusjoner i Trondheim: SINTEF og Norges tekniske universitet, (NTNU).
Programmet i 2022 starter med en heldagskonferanse som holdes dagen før vi åpner selve utstillingen, og det inkluderer også en rekke seminarer som holdes i løpet av utstillingen. Vi har også en rekke debatter om aktuelle emner. Disse debattene kan ha deltakere fra hele verden som er koblet opp via Internett.
Og så bør jeg ikke glemme å nevne Studentdagen, som holdes på den siste dagen av utstillingen. Vi har et spesielt program og inviterer studenter fra hele verden til å besøke selskaper som stiller ut. Dette har blitt veldig populært. I år hadde vi 730 studenter.
Ja faktisk. Til tross for det faktum at vi hadde færre fysiske besøkende enn i tidligere år (ca 15,000), har utstillerne uttrykt sin store tilfredshet med kvaliteten på de besøkende. Og selvfølgelig var vi, som vanlig, velsignet med det mest fantastiske
sommerværet under hele utstillingen.
Selve utstillingsområdet består av flere haller, ikke sant?

Ja, det er fem forskjellige haller, og vi prøver og samle utstillere i bestemte felt sammen. For eksempel fokuserer vi på elektronikk, som er et voksende felt, i én hall. I en annen har vi skipsbyggere, og så videre. Og så har vi våre utendørs utstillere, inkludert utstillere på vannet i Trondheim havn, som ligger bare en ti minutters spasertur fra utstillingshallen.
Jeg forstår at Nor-Fishing er en av de eldste fiskeriutstillingene i verden. Hvor lenge har dere vært i drift?
Vel, det startet i 1960, da den første utstillingen ble holdt. Deretter var den neste i 1965. Siden 1972 har vi hatt Nor-Fishingutstillinger annethvert år, og siden 1979 har det vekslet med vår andre utstilling, Aqua Nor, som fokuserer på akvakulturteknologi. Og du vil kanskje ikke tro det, men i år hadde vi en utstiller som har deltatt på hvert eneste show siden 1965, som var det andre showet vi holdt. På den tiden var han 13 år gammel og fulgte sin far, som var utstiller.
Du nevnte at den digitale versjonen vil være tilgjengelig i et helt år. Betyr det at jeg kan få tilgang til det via Internett nå?
Ja. Vi åpner det gratis for allmennheten to uker etter showet, og det forblir på internett frem til og med 31. Juli 2023.
Du finner det på vår nettside: https://aqfeed.info/e/1596


 Kari Steinsbø og Kristian Digre, Nor-Fishing.
Kari Steinsbø og Kristian Digre, Nor-Fishing.
Jeg rapporterer fra Victam Asia Health and Nutrition som ble holdt på IMPACT Exhibition and Trade Center i Bangkok Thailand.

Dette ble holdt 7.-9. September 2022 og tiltrakk seg et stort antall interessenter i dyrefôrindustrien i Asia og globalt. Møtet er virkelig et utstillingsvindu for teknologi for fôrproduksjon som milling og slipeutstyr, samt ulike typer pelleteringsmaskiner.
En rekke produkter ble vist frem - alt fra enkle dampkondisjonerte pelleteringsmaskiner, helt opp til avansert enkelt- og dobbelskrue ekstruderingsutstyr for produksjon av animalske dietter, pelletert pet-fôr og selvfølgelig akvafôr.
Det var spesiell presentasjon fra de som fremmer nye postekstrudering conditioning prosesser, som spray-belegg og vakuum-belegg av emulsjoner, oljer og stabilisatorer. Disse inkluderte løsninger for topp dressing fôr med sensitive kosttilskudd og tilsetningsstoffer som vitaminer, pigmenter og legemidler. Tørketeknologien er også svært viktig med hensyn til optimale forhold og energikostnader.
Utvikling av en sirkulær bio-økonomi
Selvfølgelig var mitt spesielle fokus på oppdrettsnæringen og vi hadde den 6. september Aquatic Asia, som ble organisert som en spesiell egen sesjon under VIV som ga en oversikt over noen av de definerende nøkkelområdene for forskning og utvikling innen fiske- og krepsdyr-ernæring .
Jeg var hovedtaler og også vert sammen med Roger Gilbert og Tuti Tan fra Perendale Publishing Ltd. Jeg snakket om den nyeste visjonen om å skape en sirkulær bio-økonomi og ga et eksempel på min egen forskning innen gjæret hveteprotein avledet fra bioetanolproduksjon; enten fra bio-drivstoff eller drikkevareindustrien som bryggerier og drikkbare alkoholbedrifter.
Det er betydelig omfang for utnyttelse av fermentert mais- eller hveteprotein i fisk og rekefôr og utvikling av deres funksjonelle, samt deres ernæringsmessige egenskaper. Andre kollegaer snakket om potensialet for akvafôr i Thailand i forhold til et bredt spekter av arter hjemmehørende i Asia, som pangasius, snakehead, tilapia, grouper og seabass. Tilapia er en svært viktig fisk for denne regionen.
Dr. Loc Tran fra Vietnam snakket om helseledelse og ernæringsmessige tilnærminger for å oppnå mer robuste reker. Dette var også et tema jeg tok opp i min andre forelesning.
Dr. Noratat Prachom snakket om mulighetene for en biosirkulær grønn økonomisk modell for bærekraftig akvakultur og akvafôrproduksjon ved hjelp av case-studier i Thailand.
Vi hadde også gleden av å ha Dr RAM C Bhujel fra AIT (Asian Institute of Technology) med sin omfattende erfaring fra den thailandske havbruksnæringen, og han ga oss et meget positivt syn på fremtiden. Lukas Manomaitis, som representerer USSEC Aquaculture Technical Program Contractor presenterte en optimistisk revurdering av bruk av soyabønnemel som en ansvarlig kjerneingrediens for akvafôr.
Dr. Eckels Viktor Eckel gjorde virkelig inntrykk med sine produkter når det gjelder hvordan fytogene fôrtilsetningsstoffer kan håndtere akvatisk dyreproduksjonshelse med fokus på overlevelse hos tilapia og reker etter patogene utfordringstester med data fra eksperimentelt arbeid på funksjonelle immunrelaterte modulatorer.
På samme måte ga Dr. Octavio Castro en svært informativ presentasjon om hvordan Phileo har fremmet skadebegrensningen i hvordan patogener samhandler med tarmen, og hvordan deres gjærbaserte produkter kan adressere denne balansen for å øke helsen til fisk og reker i praksis.
På messen var det mye å se innen akvakultur Jeg var veldig interessert i den nederlandske standen som var vert for Insect Engineer and Insect School, som tilbyr opplæring i produksjonen av Black Soldier fluen for deres larvebasert melpulver.
Dette er noe vi har rapportert om ved mange anledninger fra en rekke kommersielle bedrifter. Jeg ble også betatt av det nye selskapet som har opprinnelse i Irland kalt Celtic Minerals, en organisasjon som har utviklet biprodukter fra høsting av materiale fra havbunnen fra råtnende tang-biomasse.
De resulterende kalsiumrike avleiringene har også et spektrum av sporstoffer som kan tilby en svært biotilgjengelig kilde til ernæring for fisk og reker i fôret, eller ved å forsterke vannmiljøet i produksjonsdammer og støtte primær og sekundær vekst av trofiske matnettverk. De større og mer kjente selskapene var også til stede, som DSM, Evonik og Trouw, med informasjon om sine spesifikke og velkjente tilsetningsstoffer og kosttilskudd.
Jeg var også i stand til å komme i kontakt med kolleger fra Frankrike like ved enden av kanaltunnelen nær Calais. Soprapeche var en gang en sterkt fokusert spesialist i marine
Samlokalisert arrangement viser framtiden for bærekraftige akvakulturløsninger og akvafôrproduksjonsløsninger Av Professor Simon J Davies, sjefredaktør for International Aquafeed, UKingredienser som høyverdig fiskemel og hydrolysater. Nå har de utvidet sin portefølje og adresserer et stort utvalg av planter og andre terrestriske spesielle høykvalitets animalske biprodukter for det lukrative pet-food markedet.
De er virkelig i forkant av hydrolyserte proteinkonsentrater som har kjente funksjonelle egenskaper med betydelig potensial i oppdrett av fisk og reker. I tillegg hadde jeg fruktbare diskusjoner med Impextraco, det belgiske selskapet som spesialiserer seg på mineraler, pigmenter, aminosyrer og antioksidanter i husdyrdietter og nå også tester sine produkter på fisk og reker.
En annen veldig interessant interaksjon var min lange prat med Eurofeed Technologies basert i Italia med sin portefølje av fôrtilsetningsstoffer.
Jeg ble imponert over tilstedeværelsen av flere asiatiske selskaper som nå utvikler helseprodukter som er forbundet med god ernæring i form av organiske kosttilskudd, immunstimulerende midler og ulike skreddersydde prebiotiske og probiotiske produkter. Dette er et aktivt område for mitt eget forskningsfokus, og jeg fant deres åpenhet for å diskutere potensialet til slike produkter ganske forfriskende og muligheter for meg til å støtte deres visjon.
Ledende produsenter av milling- og ekstruderingsutstyr
Under konferansen hadde vi et møte med senior tjenestemenn i Famsun fra Kina, hvor vi diskuterte deres agenda som ledende produsenter av milling- og ekstruderings-utstyr, som omhandler alle aspekter av korn og prosessering, dyrefôr-teknologi og selvfølgelig - har en sterk relevans for akvafôrproduksjon.
Utfordringene i både teknologiog verdenshandel dannet kjernen i diskusjonene, med mye positiv tenkning om fremtiden.
Konferansen tilbød mange sidemøter med innovasjonspriser som ble gitt til viktige suksesshistorier.
AFTAN Animal Feed and Nutrition- og GRAPAS-prisene er ettertraktede og fremhever både bedrifter og innovasjoner. Som VIP-deltaker hadde jeg gleden av å delta i en mottagelse på kvelden og en mulighet til å møte andre i en mer avslappet setting.


Buffeen var utmerket med lokale thailandske og asiatiske retter - med et utvalg av vin og øl også tilgjengelig.
En hyggelig og varm opplevelse
Å være tilbake i ansikt-til-ansikt møter var faktisk en fin opplevelse og gjorde det hele verdt turen. Det vil uten tvil bli flere besøk til lignende arrangementer dette året og sikkert i 2023.


Været var hovedsakelig behagelig og varmt, men etter en stor tørke i Europa var jeg glad for å oppleve et svært tropisk tordenvær og kraftig regn en natt – det var merkelig for meg å se en oversvømmet vei.
Mot slutten av mitt besøk fikk jeg som britisk statsborger mange uttrykk for kondolanse etter de svært triste nyhetene om Hennes Majestet Dronning Elizabeth IIs død.
Jeg vil gjerne ta denne muligheten til å takke alle som tok seg tid til å gjøre dette av godhet og sympati.





Taipei, Taiwan SMART Agriweek & Taiwan International Fisheries and Seafood Show var planlagt holdt fra 29. september til 1. oktober 2022, på 4/F, Tainex Hall 1, og har allerede invitert kjøpere fra Thailand, Vietnam, Singapore, Malaysia, India, Indonesia og andre land for å delta i matchmaking.

Med den nye datoen forventer man å tiltrekke seg 15 000 innenlandske og utenlandske profesjonelle kjøpere fra mer enn 30 land for å besøke showet. I tillegg vil det fysiske arrangementet også bli holdt fra 29. oktober, og det varer i 31 dager.
En one-stop løsning «Go Smart, Grow Together» er slagordet til Taiwan Smart Agriweek. Utstillingen vil ha fire paviljonger: AGI Tech, Agri Livestock, Agri Plus+ og Agri Foods, for å vise frem den nyeste teknologien innen intelligent landbruk, bærekraftig og sirkulært husdyrhold, miljøvennlig oppdrett, smart husdyrhold, presisjonslandbruk, ernæring og helse, landbruk, kulde-kjede, matforedling og integreringstjeneste.
I forbindelse med Taiwan SMART Agriweek er Taiwan International Fisheries and Seafood Show den eneste B2B messen for fiskerisektoren i Taiwan. Disse to utstillingene har som mål å
tilby en one-stop løsning og hjelpe alle parter i bransjen til å ha en sømløs transformasjon.
Under utstillingen vil det være online / offline matchmaking-møter, dusinvis av profesjonelle fora, matlagingsshow, distribusjon av "lucky bags" og mange andre aktiviteter. For å fortsette utvidelsen av utstillingen vil arrangørene holde Animal Precision Nutrition Forum OMO i Tainan fra 26. til 27. oktober 2022.
Den intelligente transformasjonen av landbruks-, fiskeri- og husdyrindustrien i sørøstasiatiske land har skapt sterk markedsetterspørsel. Ettersom Taiwan deler samme høye temperatur og fuktighet, er Taiwans teknologier og produkter innen landbruk, fiskeri og husdyr i stand til å bli brukt i regionen.
Derfor er det 30-dagers online-showet «Taiwan Smart Agriweek» og «Taiwan International Fisheries and Seafood Show» den perfekte kommunikasjonsplattformen for å demonstrere den komplette industrikjeden som spenner fra genetikk, avl, planting, ernæring antibiotikaoppdrett til kuldekjedetransport fra Taiwan til regionen. Med forretningsnettverket og den profesjonelle utenlandsmarkedsføringen fra AMB Tarsus Group vil utstillingene trenge inn i
landbruksbedrifter og selskaper i Sørøst-Asia.
- Teknologiene og utstyret til Taiwans jordbruks-, fisk- og husdyrindustri er i tråd med Sørøst-Asias miljø- og klimaforhold. Samarbeidet med AMB Tarsus Group vil definitivt skape mer samarbeid mellom kjøpere og selgere og fremme Taiwans beslektede næringer over hele verden, sier Irene Liu, daglig leder for My Exhibition Co, ltd.
Virtuelle og on-site modeller
Til tross for pandemi-trusselen i fjor, brukte arrangørene smart nok virtuelle og on-site modeller på utstillingen. Mass Digital Marketing og internasjonale kringkastingsmedier økte den internasjonale eksponeringen og ga en rekke forretningsmuligheter for landbruks- og akvakulturnæringen.
Selv om de gjennomgikk en endemisk ugunstig situasjon, tiltrakk begge arrangementene seg utstillere fra 36 land, og antall besøkende nådde 11000. Arrangementet førte også til ukentlige transaksjoner på USD 36.32 millioner.
I år vil de fortsette den vellykkede utstillingsmodellen OMO for å motvirke eventuelle begrensninger på reiser under pandemien og strebe etter flere samarbeidsmuligheter for utstillerne.
For mer informasjon, besøk Taiwan International Fisheries and Seafood Show sin nettside: https://aqfeed.info/e/1595

SAS Laboratories Phode +33 5 63 77 80 60 www.phode.com PROFIL: aqfeed.info/e/1644
R-Biopharm +44 141 945 2924 www.r-biopharm.com PROFIL: aqfeed.info/e/1645
Romer Labs +43 2272 6153310 www.romerlabs.com PROFIL: aqfeed.info/e/1610
Romer Labs ble grunnlagt i Washington i 1982, og har gjennom årene blitt en ledende leverandør av diagnostiske løsninger for landbruks-, mat- og fôrindustrien.

I dag tilbyr Romer Labs et bredt spekter av innovative diagnostiske løsninger som dekker mykotoksiner, matpatogener, matallergener, gluten, GMO, veterinærpreparater, og kontaminanter. Videre opererer de fire akkrediterte, fullservice laboratorier i Østerrike, Storbritannia, USA og Singapore. Ved hjelp av banebrytende teknologi innen kromatografi og immunologisk analyse tilbyr laboratoriene sine tjenester for analyse av mykotoksiner, matallergener, kjøttpeeling, VDR og GMO.

Romer Labs er i forkant av diagnostisk teknologi og utvider stadig sin produkt- og tjenesteportefølje for å møte dine kontinuerlig utviklende behov. Hovedmålet hos Romer Labs er å tilby vitenskapelig grundige produkter av høy kvalitet og en eksepsjonell service, i tråd med sinmisjon – noe som gjør verdens mat tryggere®

Bühler
FAMSUN +86 514 85828888 www.famsungroup.com PROFIL: aqfeed.info/e/1034
FrigorTec GmbH +49 7520 91482-0 www.frigortec.com aqfeed.info/e/1652
IDAH +866 39 902701 www.idah.com PROFIL: aqfeed.info/e/1615
Ottevanger +31 79 593 22 21 www.ottevanger.com PROFIL: aqfeed.info/e/1621
Wenger Manufacturing +1 785-284-2133 www.wenger.com PROFIL: aqfeed.info/e/1616 Yemmak +90 266 733 83 63 www.yemmak.com PROFIL: aqfeed.info/e/1617
Zheng Chang +86 2164184200 www.zhengchang.com PROFIL: aqfeed.info/e/1623
Adisseo +33 1 46 747104 www.adisseo.com PROFIL: aqfeed.info/e/1624
Aller Aqua +45 70 22 19 10 www.aller-aqua.com PROFIL: aqfeed.info/e/961
Alltech +44 1780 764512 www.alltechcoppens.com

PROFIL: aqfeed.info/e/1625
Anpario +44 1909 537 380 www.anpario.com PROFIL: aqfeed.info/e/1626
Anpario plc er en uavhengig, internasjonal produsent og distributør av naturlige fôrtilsetninger for akvakulturhelse, ernæring og biosikkerhet. Våre spesialiserte fôrteknologier er både innovative og skreddersydde for å møte den stadig økende befolkningens behov for sunn mat.
Anparios fôrtilsetningsstoffer selges i over 80 land gjennom etablerte salgs- og distribusjonsnettverk, som inkluderer en rekke heleide datterselskaper i viktige markeder rundt om i verden. Vi har over 30 års kompetanse innen landbruk og akvakultur, og arbeider med viktige forskningsinstitutter og universiteter over hele verden både innen utvikling og evaluering av våre innovative og banebrytende produkter.
Anparios produktportefølje av innovative løsninger fungerer i harmoni med de naturlige aspektene ved både dyrets biologi og miljø, og skaper ansvarlige løsninger for å optimalisere helse, vekst og lønnsomhet på en bærekraftig måte.

Vår misjon er å tilføre verdi gjennom livet til dyr, slik at vi kan hjelpe våre kunder med å oppnå optimal dyreytelse, med påvist avkastning på investeringen, og øke lønnsomheten i dagens moderne produksjonssystemer for havbruk. Våre teknologier er utviklet, produsert og sendt direkte fra vårt kvalitetssikrede produksjonsanlegg i Storbritannia.
Biorigin www.biorigin.net
PROFIL: aqfeed.info/e/1627
GePro +49 54415 925252 www.ge-pro.de aqfeed.info/e/1656
Grup Dibaq +34 921 574 286 www.dibaqacuicultura.es PROFIL: aqfeed.info/e/1604
Grand Fish Feed +202 20 650018 www.grand-aqua.com PROFIL: aqfeed.info/e/1628
Liptosa +34 902 15 77 11 www.liptoaqua.com PROFIL: aqfeed.info/e/1608
Phileo (Lesaffre Animal Care) +33 3 20 81 61 00 www.lesaffre.fr PROFIL: aqfeed.info/e/1629
Clextral +1 813 854
When maximum volume matters, the Wenger AQUAFLEX XT High Capacity Aquafeed Extruder is the choice, processing up to 12,000 kg/hour. Equipped with either our High Shear Conditioner (HSC) or High Intensity Preconditioner (HIP), the AQUAFLEX XT is ideal for aquatic feeds as small as 0.5 mm. Precise control of finished product density delivers either high capacity floating or







Hydronix
+44 1483 468900 www.hydronix.com PROFIL: aqfeed.info/e/1634
FAWEMA / The Packaging Group
+49 22 63 716 0 www.fawema.com PROFIL: aqfeed.info/e/1635
Anderson
www.andersonfeedtech.com aqfeed.info/e/1658

IDAH +866 39 902701 www.idah.com PROFIL: aqfeed.info/e/1615
Clextral
+1 813 854 4434 www.clextral.com PROFIL: aqfeed.info/e/1620
IDAH +866 39 902701 www.idah.com PROFIL: aqfeed.info/e/1615
PTN +31 73 54 984 72 www.ptn.nl PROFIL: aqfeed.info/e/1636
Andritz
+45 72 160300 www.andritz.com PROFIL: aqfeed.info/e/1619
Buhler AG +41 71 955 11 11 www.buhlergroup.com PROFIL: aqfeed.info/e/1614
Clextral +1 813 854 4434 www.clextral.com PROFIL: aqfeed.info/e/1620 Dinnissen BV +31 77 467 3555 www.dinnissen.nl PROFIL: aqfeed.info/e/1633
FAMSUN +86 514 87848880 www.muyang.com PROFIL: aqfeed.info/e/1034
Ottevanger +31 79 593 22 21 www.ottevanger.com PROFIL: aqfeed.info/e/1621
Yemmak +90 266 733 83 63 www.yemmak.com PROFIL: aqfeed.info/e/1617
Yemtar +90 266 733 8550 www.yemtar.com aqfeed.info/e/1657
Zheng Chang +86 2164184200 www.zhengchang.com
PROFIL: aqfeed.info/e/1623

ACE Aquatec
+ 44 7808 930923 www. aceaquatec.com PROFIL: aqfeed.info/e/764
DSM +43 2782 8030 www.dsm.com PROFIL: aqfeed.info/e/1605
Royal DSM er et globalt, spesialselskap innen helse, ernæring og biovitenskap, og bruker vitenskap for å forbedre helsen til mennesker, dyr og planeten. DSM har som formål å skape et lettere liv for alle. DSM’s produkter og løsninger tar for seg noen av verdens største utfordringer samtidig som de skaper økonomisk, miljømessig og samfunnsmessig verdi for alle sine interessenterkunder, ansatte, aksjonærer og samfunnet for øvrig. DSM og tilknyttede selskaper sysselsetter rundt 23,000 mennesker over hele verden og har et årlig nettosalg på rundt 10 milliarder Euro.
DSM bruker sin vitenskap til å levere positive transformasjoner i skala for så mange mennesker som mulig i dag og i generasjoner som kommer, opererer innenfor begrensningene til verdens begrensede ressurser. DSM har som mål å redefinere hvordan de lever og jobber for å skape et mer rettferdig, mer velstående og mer bærekraftig samfunn.
DSM Animal Nutrition og Health-konsernet tilbyr kundene en komplett portefølje av produkter, løsninger og tjenester for bærekraftig og lønnsomt dyreoppdrett. Selskapets tre dedikerte forretningslinjer dekker Precision Services, Performance Solutions + Biomin® og Essential Products.
Større presisjon i dyreoppdrett er nøkkelen til en mer bærekraftig og lønnsom fremtid. Deres Precision Services bruker den nyeste dataanalysen og diagnostikken for å forbedre dyrehelse, livstidsytelse, ressursbruk og miljøavtrykk – samtidig som de reduserer risiko og skaper større verdi. Å forbedre bærekraften og lønnsomheten til dyrehold er sikret.
Deres brede portefølje leverer det nivået av funksjonell ernæring som trengs for at industrien skal møte utfordringene med bærekraft, dyrevelferd og fôrkvalitet.
Viktig ernæring er grunnleggende for sunt, bærekraftig animalsk protein. Deres essensielle produkter gir viktige næringsstoffer for dyrets sunne vekst og utvikling – levert til kunden på den mest fleksible, skreddersydde måten.
Som et målrettet selskap har DSM i årevis levert vitenskapsbaserte produkter, tjenester og banebrytende innovasjon som er grunnleggende for helse, trivsel og bærekraft hos husdyr. Med økende etterspørsel etter bærekraftig animalsk protein som er trygg, næringsrik og rimelig, hjelper DSM industrien med overgangen til en mer bærekraftig fremtid for å møte denne komplekse utfordringen. #WEMAKEITPOSSIBLE
IDAH +866 39 902701 www.idah.com PROFIL: aqfeed.info/e/1615
Etter å ha studert farmasi ble Pierre Pienaar interessert i emballasje og i 1984, og etter å ha blitt ansatt i et stort farmasøytisk selskap, ble han oppmerksom på en rekke emballasje-relaterte problemer i den farmasøytiske verden.
Pienaar er emballasjetekniker i sin egen globale emballasjekonsulentvirksomhet, PackTech Solutions Pty Ltd og har lang erfaring innen farmasøytisk industri og næringsmiddelindustrien med over 35 års erfaring innen emballasjevitenskap og ingeniørfag, samt relaterte emner.
Han er nå nasjonal utdanningsdirektør, tidligere president for AIP og tidligere visepresident for verdens emballasjeorganisasjon (WPO), ansvarlig for global emballasjeutdanning.
Han har forelest i teknologi og vitenskapen om emballasje ved ulike universiteter og institusjoner rundt om i verden de siste tretti årene, og han blir regelmessig innkalt som ekspertvitne i rettssaker på grunn av sin omfattende erfaring i emballasjevitenskap, emballasje-engineering og tilhørende teknologier.
I tillegg til en Master of Science grad (Packaging Engineering / Technology) fra Brunel University i Storbritannia har han også en Master of Manufacturing og Production fra University of Hertfordshire, Storbritannia. Pienaar er en sertifisert innen emballasjeteknikk i over 60 land og har også et dobbelt professorat innen emballasjeteknikk og er nåværende president i verdens emballasjeorganisasjon (WPO).
Hvilke aspekter ved emballasje ønsker du å se adressert i tiden fremover og hvorfor?
Bærekraft er et populært ord for tiden, men jeg vil foretrekke å definere dette i en emballasjesammenheng.
Vi må utdanne flere mennesker rundt om i verden om relevansen til emballasje. Spesielt gjelder dette å gjøre det rette med emballasjen når vi har fjernet innholdet. I mange land har man en holdning eller til og med en kultur om emballasje når det gjelder resirkulering. Det er alltid vanskelig å endre en kultur eller et tankesett.
Så jeg tror vi må starte med å utdanne de små, i 1, 2 og 3 klasse. Dette er en alder da barn er svært påvirkelige og da de kan påvirkes til å forstå hva de skal gjøre med emballasje og hvordan de best kan sikre at alt blir resirkulert og ikke bare kastet på gaten, i vannet, på strendene og dermed ødelegge naturen vår.
Når vi utdanner den yngre generasjonen vil de påvirke sine foreldre og besteforeldre til å gjøre det rette med emballasje. I løpet av de påfølgende årene utvikler vi en ny kultur over hele verden. Jeg har personlig sett at dette virker ettersom jeg har gjort dette i mitt hjemland de siste 16 årene og har sett endringen.
Dette tror jeg er sann bærekraft med hensyn til emballasje og det fungerer. Det vil ta tid, men vi må starte et sted, og jo raskere dess bedre. Det finnes ingen plan B til en alternativ planet.
Overdreven bruk av emballasje er ofte gjenstand for negativ publisitet, men gitt behovet for å beskytte matvarer mot forurensning eller forråtnelse under transport og levering, hva kan bransjen gjøre for å løse problemene med for mye emballasje samtidig som maten er trygg?
Dette er noe vi spesifikt underviser i på våre kurs over hele verden. Ofte er det mangel på teknologi-forståelsen av emballasje. Vi har mange tilfeller der materialet har blitt ‘beefed’ opp for å forbedre barrieren, eller for å øke beskyttelsen av innholdet, hvor det har vært helt overflødig. I nesten alle de tilfellene jeg har vært involvert i disse siste 35 årene i bransjen, forstår og aksepterer kunden det når en forklaring blir gitt og en bedre alternativ løsning tilbys. Vi har for mange ikke-kvalifiserte mennesker som tar viktige beslutninger når de rett og slett ikke har kunnskap om vitenskap og teknologi til å ta en informert beslutning om å øke beskyttelsen. Løsningen som vi tar for oss globalt er å lære opp flere personer i emballasjebransjen om materialvitenskap, emballasjeteknikk og emballasjeteknologi.
Det er behov for å redusere mengden av ikkebiologisk nedbrytbar plast. Hva gjør bransjen for å minimere den mengden plast som kommer inn i miljøet?
Vi trenger at flere land blir engasjert i å redusere mengden ikke-biologisk nedbrytbar plast. Foreløpig er det en ‘for hard kurv’ for mange utviklingsland. I tillegg vil det i utgangspunktet koste mye, pluss at mange av disse utviklingslandene forteller meg at de har viktigere saker å konsentrere seg om, for eksempel skaffe mat til folkene er høyere på deres agenda enn emballasjeproblemer.
Det er også utviklede land som gjør de samme feilene, og for dem er det et spørsmål om bare å slutte å utsette det uunngåelige og gjøre ting anderledes. De er alle fullt klar over at det er riktig å gjøre det, men i mange tilfeller venter de på lovgivning for å gjennomføre endringen.
Det er ingen tvil i mitt sinn at forandringen er igang, mer så i noen land enn andre. Men generelt er vi alle klar over at fremtiden er dyster hvis vi ikke gjør noe. Praktisk talt alle regjeringer rundt om i verden er klar over dette.
Den måten vi for tiden bruker opp verdens naturressurser krever nesten to planeter. Hvis vi ikke gjør noen av de bærekraftige endringene som vi foreslår over hele verden, pluss at vi ikke resirkulerer alle emballasje, så vil det kreves nesten tre planeter innen 2050.
Men hvis de tiltak som miljøvernerne foreslår blir implementert over hele verden med umiddelbar effekt, kan vi være tilbake på sporet og leve innenfor våre midler på planeten jorden, med en balansert netto effekt på naturressursene.
Endringen vil skje, det er mer et spørsmål om hvor snart alle vil innse at beslutningene som vi tar nå vil påvirke generasjonene i 2050 og deretter. Disse påvirkningene vil oppleves som ekte for alle i løpet av de neste 10 årene, men for tiden er det bare snakk og de blir ikke ansett å være ‘virkelige’ nok for den almene befolkningen til at de forstår konsekvensene og de fremtidige resultatene av ikke å gjøre noe tidligere.
Poenget er at vi alle må gjøre vår jobb og ikke la det være opp til supermaktene i verden, eller de avanserte økonomiene, eller bare noen få land.

VideoRay har utnevnt Brad Clause som kundeansvarlig for sine offshore fornybar vind-energi, havbruk og shipping markeder. Han bringer mer enn 20 års erfaring med Subsea ROV oppdrag til selskapet.
Før han begynte hos VideoRay, jobbet Clause for Oceaneering International og C-Innovation. Han har lang erfaring med kundefokuserte ROV-operasjoner som spesialiserer seg på offshore fornybar energi.
– Brads erfaring med å lede team som jobber i tøffe undervannsmiljøer og hans tankesett som setter kunden først, matcher selskapets filosofi. Han er ideell for oss, og vi er glade for å ha ham ombord, sier Chris Gibson, visepresident for salg og markedsføring.
«Noe av det jeg er mest spent på er VideoRays globale rennomé for personlig kundestøtte og hvordan jeg kan bidra til dette engasjementet,» sier Brad Clause.
Sustainable Aquaculture Innovation Centre (SAIC) har utnevnt Jillian Couto-Phoenix som ny leder for ferdigheter og talent, til å lede sitt spekter av karriereutviklingsprogrammer og bidra til å tiltrekke neste generasjons talenter inn i sektoren.

I sin nye rolle i SAIC, vil Couto-Phoenix overvåke innovasjonssenterets opplærings-, ledelsesog sektorengasjements-programmer. Hun vil jobbe tett med akvakulturfagfolk, høyskoler og universiteter om kompetanseinitiativer samt utvikling av SAICs støtte til praksisplasser, kandidater og mastergradsstudenter.
– Jeg gleder meg til å bli med i SAIC og bruke min erfaring på innovasjonssenterets opplærings- og ferdighetsprogrammer, sier MS Couto-Phoenix.
– Jillian er et utmerket tilskudd til teamet vårt, og bringer en mengde erfaring når det gjelder bærekraftig kompetanseutvikling. Denne rollen er avgjørende for å tilpasse sektorens behov til nye talenter i starten av deres karriere innen akvakultur, sier Heather Jones, adm. dir. i SAIC.
Det ledende bioteknologiselskapet Biomega har utnevnt Peter Krüger som teknisk leder for selskapets nye bioraffineri som ligger ved havnen i Hirtshals i Danmark.
Krüger kommer til Biomega fra Royal Greenland, hvor hans stilling var teknisk leder ved en fabrikk for reker og kveite på Grønland, og på sitt danske hovedkontor i Aalborg. Hans ansvarsområde var innen drift og vedlikehold, maskinoptimaliseringsanalyse, samt ulike konstruksjons- og prosjektledelses-roller.
– Vi er glade for at Peter har sluttet seg til vårt voksende team her i Danmark, sier Jarl Knudsen, COO i Biomega. «Med sin brede erfaring i å håndtere store tekniske prosjekter vil han spille en nøkkelrolle for å sikre at den nye fabrikken er oppe og går raskt med minimal nedetid.»
– Den nye fabrikken i Hirtshals representerer en ny utfordring for selskapet, og jeg er virkelig beæret over å bli en viktig del av denne sirkulære reisen, avslutter Krüger.
En av ekspertene på slambehandling i akvakultur, Blue Ocean Technology AS, vokser raskt med et økende antall prosjekter på land og til sjøs i inn- og utland – og utvider staben sin igjen.
Med erfaring fra å jobbe med automatisering i sekvensielle systemer, generell PLC- og HMIprogrammering, er Kristoffer Slettehaug blitt ansatt som automatiseringsingeniør. Han kommer fra Siemens Energy, hvor han jobbet med automasjons- og kontrollsystemer for sikkerhet på offshoreinstallasjoner, alt knyttet til å gjøre maskinvaren så effektive som mulig.

Slettehaug vil være ansvarlig for videreutvikling av all automatisering i tråd med Blue Ocean Technology sitt mål om å være ledende innen slamområdet: Systemer for innsamling og rapportering av data, analyse og rapportering (ESG).


Blue Ocean vokser og ansetter en ny COO
Blue Ocean Technology AS, et selskap som vokser raskt med økende antall prosjekter på land og til sjøs i inn- og utland – og utvider staben sin igjen. Thomas Tveiten Lewis har blitt ansatt som COO –og har tiltrådt stillingen.
Hans tidligere arbeidserfaring inkluderer en periode hos Rolls Royce Power Systems/Bergen Engines innenfor områdene prosjektledelse og systemdesign, og sist for Greensight (en del av Greenstat ASA) som prosjektleder og energirådgiver.
Som produksjonsleder/COO ved Blue Ocean Technology vil Tveiten Lewis ha et overordnet ansvar for all produksjon av systemer for kunder i inn- og utland.





